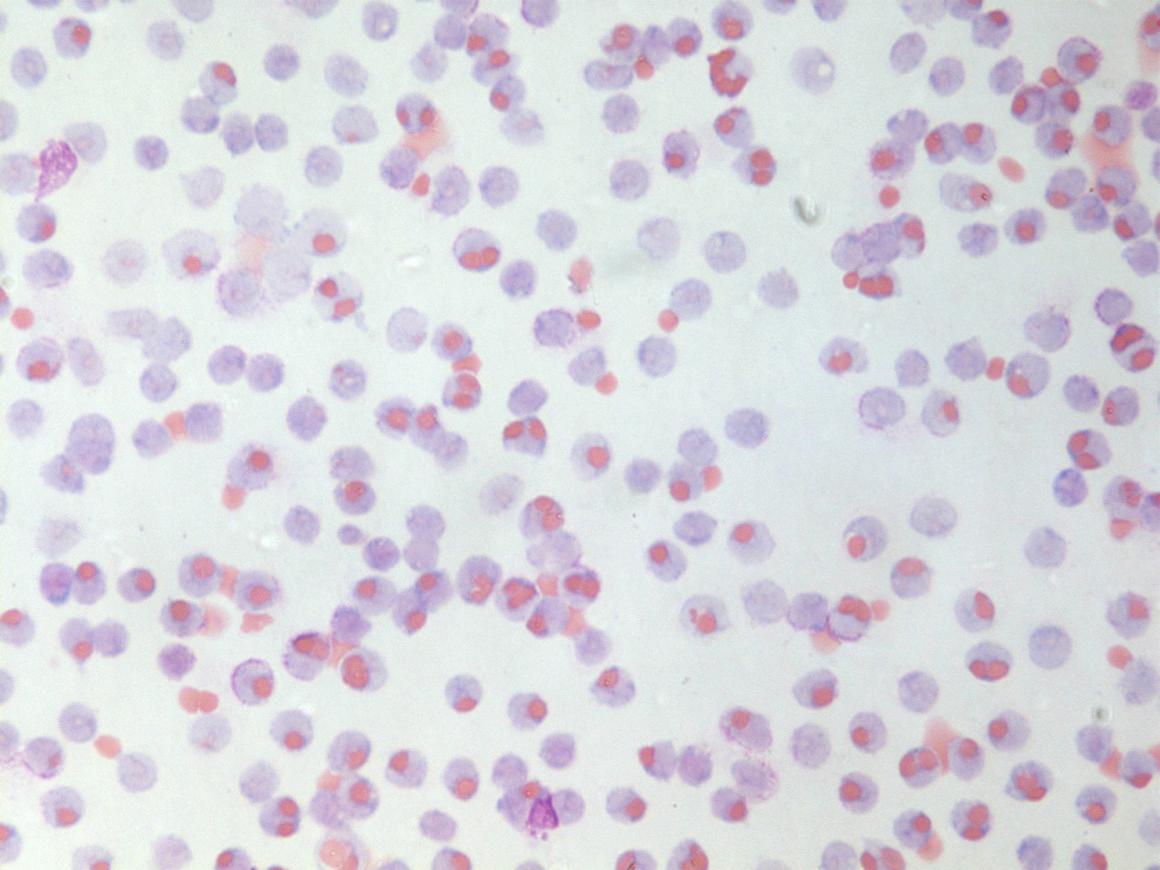

The CBR aims to improve the health and well-being of patients through innovative research in blood and blood-related processes.

Patient-driven. Innovative. Community.
Over the past year, donor support has helped us develop novel approaches to battle severe bleeding in rural areas, delineate the mechanisms of inflam matory diseases, and increase the quality of blood products used in trans fusions — only a few examples among many pioneering discoveries. With your continued support, the CBR will further transform innovative ideas into life-enhancing solutions.
The CBR needs you to help fund our programs, which range from $50 to $100,000. We invite you to explore opportunities at the CBR where your partnership with us will result in positive impacts on education, training and meaningful research. Examples of initiatives that need your support include:
Reward leadership in students and staff with the Neil Mackenzie Mentorship Award $50
Expose trainees to diverse career opportunities with the CBR Career Night $1,000

Jumpstart a postdoctoral fellow’s career with the Postdoctoral Transition Award $5,000

Support a clinical fellow in Translational Research Studies $75,000 Make a CBR Symposium possible $25,000$100,000
Explore further: CBR.ubc.ca/support-us Dana Devine, MA, PhD Director, Centre for Blood Research Tel: 604.822.7270 | Email: ddevine@pathology.ubc.ca
• Improve the quality and safety of blood product collection, storage and delivery
• Create new knowledge to better treat bleeding and clotting disorders
• Develop novel approaches to modulate the immune system to treat inflammation and infections and promote wound repair

• Support student research through competitive undergraduate, graduate, and postgraduate awards
• Offer a range of stimulating educational symposia, workshops, and seminars
• Provide cutting-edge career development opportunities for our trainees
PUBLISHED BY Knowledge Translation Committee
Kristine HoCONTRIBUTING
Alexandra Witt*
Ardin Sacayanan
EDITORS
Cecilia Haymin-Kim
Christina Pan Colton Strong
Dr. Geraldine Walsh*
Kristine Ho*
Kisa Naqvi
Loulou Cai*
Maria-Elizabeth Baeva
Marie-Soleil Smith
Melody Weng
Dr. Michael Hughes*
Nancy Yang*
Paniz Ghavimi
Dr. Parvin Bolourani*
Rhonda Thygesen
Sarah Bowers*
Steven Jiang
Tien Do
Waris Bhatia
* indicates Editorial Board member
COVER ART “Picrosirius red staining of collagens in mouse fat tissue”, Nooshin Safikhan BLOG cbr.ubc.ca
FACEBOOK @cbrubc
TWITTER @CBR_UBC INSTAGRAM @cbr_ubc
LINKEDIN Centre for Blood Research at UBC
The CBR magazine is published by the Centre for Blood Research, with many articles written and edited by the CBR Knowledge Translation (KT) Committee, a group of undergraduates, graduate students, postdoctoral fellows, research associates, and technicians who are interested in science writing, blogging, and mixed media communications. It is distributed free of charge to CBR and UBC alumni, friends, and the scientific community. Opinions expressed in the magazine do not necessarily reflect the views of the centre or the university.
Address correspondence to: The Centre for Blood Research 4th Floor, Life Sciences Centre 2350 Health Sciences Mall Vancouver, BC, Canada V6T 1Z3


The KT Committee publishes at CBR News (cbr.ubc.ca) and covers a wide range of topics, from recent research highlights and opinion pieces on science and academia, to event coverage and CBR initiatives. If you are interested in participating in the KT Committee, email Kristine at: kristine.ho@ ubc.ca or talk to one of the members! All undergraduates, graduate students, PDFs, RAs, and technicians are welcome to join.
CONTACT kristine.ho@ubc.ca
Science beyond academia
this issue
4 6 8 9
››

Dr. Kelly Brown leads evaluation of the utility of adult-defined biomarkers in pediatric vasculitis with CIHR Fall 2021 Project Grant
Revisiting cold-stored platelets: An effort to improve patient care and storage feasibility


Fine-tuning fibrin(ogen)
“Squeeze-ability” of a red blood cell: The deformability of red blood cells is a useful biomarker for storage quality
A day in the life of a honeybee scientist
›› 14 16 21 in
Norman Bethune Symposium 2022: Personalized medicine in focus
2022 CBR Summer Students tour the netCAD Blood4Research Facility
CBR Events, Socials & Activities
CBR Travel Awards: Attending the ISTH 2022 Congress
Michael John Page Postdoctoral Fellowship Award Recipient 2022: Dr. Miffy Hok Yan Cheng
Mopelola Akinlaja wins second place in the UBC 3MT competition, encourages grad students to challenge themselves

UBC 3MT finalist calls for more science communication
Neil Mackenzie Mentorship Excellence Award Recipient: Dr. Samantha Grist
PEOPLE
5 17 20 21 ›› 28 18 35
Meet the Graduate Award Program (GAP) Cohort 2022-2023!
OPINION
30 ›› 32 34
CBR alumni: Get in touch!
SPECIAL FEATURE
CBR Kudos & Laurels Special Thanks & Sponsors 19 34 35
››
10 12 3
 BY: CECILIA HAYMIN KIM, CBR SUMMER STUDENT ALUM
BY: CECILIA HAYMIN KIM, CBR SUMMER STUDENT ALUM
UBC Centre for Blood Research (CBR) researcher Dr. Kelly Brown, PhD, was recently awarded funding from the Canadian Institutes of Health Research (CIHR) in the Fall 2021 Project Grant competition. The following is a piece written by CBR Knowledge Translation (KT) Committee author Cecilia, who sat down with Dr. Brown to learn a little more about the funded project and research in the Brown Lab.
Vasculitis is a disease characterized by inflammation of blood vessels which carry oxygen to critical organs of the body. While treatment of vasculitis with disease-modifying anti-rheumatic drugs (DMARDs) and corticosteroids can be lifesaving, finding a drug regimen that reduces unwanted side effects is a difficult process. This is particularly true in children, since vasculitis is rarer in children, and most of the knowledge on vasculitis in children — and how to best treat it — stems from studies in adults.
Towards finding the right drug and dosage to use for treatment, researchers that study vasculitis in adults have found a few biomarkers in the blood and/or urine that can help predict which patients are at higher risk of developing severe disease. Funding from the Canadian Institutes of Health Research (CIHR) was awarded to CBR researcher Dr. Kelly Brown in the Fall 2021 Project Grant competition to evaluate whether the prognostic biomarkers identified for vasculitis in adults can also be used to help inform treatment decisions
for children with vasculitis.
Dr. Brown is a Principal Investigator at BC Children’s Hospital Research Institute and an Assistant Professor in the Division of Rheumatology within the UBC Department of Pediatrics. As the Division’s first full-time basic scientist, work in Dr. Brown’s lab on the campus of BC Children’s Hospital focuses on addressing questions derived from clinical problems encountered by children with rheumatic disease and aims to help bridge the benchto-bedside gap.
The CIHR funding is “really rewarding,” said Dr. Brown, “as it gives us the opportunity to work with a rare but important disease in children.”

The importance of the project is highlighted by the numerous collaborators that Dr. Brown and coPrincipal Investigator in the Division of Rheumatology, Dr. David Cabral (MBBS), are working with in Canada, the USA, and various countries across the globe. Dr. Brown explained a clinical registry of children with vasculitis was established by Dr. Cabral (2007), which established a foundation for a previous (2012) CIHR
grant and led to the creation of “the largest international network of doctors and scientists in the world studying vasculitis in children.” Dr. Brown emphasized that since vasculitis is rare in children, these collaborations help provide more data for the project, which can grow the studies so that there is more confidence and power in the results.
Dr. Brown says that working closely with clinicians is key to doing research that contributes to better care for patients. “[We] are excited to use science to advance our understanding of diseases, while working in the translational blended laboratory setting.”
The Center for Blood Research wishes to congratulate Dr. Brown and her team on the grant and is excited for the meaningful research that is in the works!
The Brown Lab studies markers and mechanisms of inflammation for improved therapeutic management of rheumatic diseases in children. C
CONFERENCE: INTERNATIONAL SOCIETY ON THROMBOSIS AND HEMOSTASIS (ISTH) 2022 CONGRESS, JULY 9-13, 2022
LOCATION: LONDON, UK

The International Society on Thrombosis and Hemostasis (ISTH) 2022 Congress is the most important annual meeting in the field of blood research. The interdisciplinary conference features basic, translational and clinical research in a diverse range of fields within hemostasis including bleeding disorders, coagulation and immunity, to name a few. ISTH also offers industry partners the opportunity to share recent advancements in bloodrelated biotherapeutics and facilitates networking events for attendees. I was accepted to give a poster presentation describing the recent achievements we have made in using lipid nanoparticles (LNPs) to genetically engineer platelets for therapeutic applications. My primary goals for attending this conference were to disseminate research findings with the greater blood community and to identify key collaborations that would enable us to drive the project forward.
I started my PhD at UBC mid-pandemic in September 2020 and had yet to attend an international conference in-person until the ISTH 2022 Congress. The opportunity to attend the ISTH 2022 Congress in-person was an eye-opening experience and my first introduction to the international blood community. My attendance has enumerated benefits, both academically and professionally. The theme of ISTH 2022 Congress was centered around research that has been
conducted since the beginning of the pandemic and served as an opportunity for leaders in the community to provide status updates on the research in respective fields. Although there were hundreds of oral communication sessions and interesting poster presentations, the core purpose of my attendance was to not only share my own research, but also advance my knowledge on specific topics including: gene therapy, platelet-derived extracellular vesicles and in vitro platelet production. Thanks to support from CBR, I had the opportunity to engage many interesting oral communication sessions and presentations that expanded my knowledge on the respective topics.
The poster that I presented described our successes transfecting platelets with LNPs and the effects of LNPs on platelet function. Directly expressing exogenous proteins in platelets is something that has not been demonstrated before and sharing our findings with the greater blood communality garnered significant excitement. Specifically, I showed that platelets engineered with LNPs can express luminescent enzymes and have similar in vitro characteristics compared to unmodified platelets. The responsiveness of LNP-treated platelets to physiological agonists and their behavior in forming clots was not significantly different than unmodified platelets. While giving the presentation, I was approached by members of the platelet research
community and industry representatives that were excited by our platelet technology. We are now actively pursuing new collaborations with national and international researchers
I would like to thank CBR for supporting my attendance of the ISTH 2022 Congress in London. The academic and professional benefits garnered at this event will be invaluable to both research and future career success. C
Learn more about CBR Travel Awards at: www.tinyurl.com/cbrtravelawards

Have you ever thought about how your blood is stored after you donate it? Since most of the readership of this article will likely be blood researchers, I’m sure the answer is yes.

Platelets have been effectively stored the same way for decades, but is there a better way? There are numerous tasks that are a part of your day-to-day that you do a certain way because that is the way it has always been done. Have you ever considered questioning the status quo and finding out if the way we do it now, and the way we’ve been doing it for years, is really the best way?
In this interview I caught up with Wayne Zhao, a PhD candidate in Dr. Dana Devine’s lab, to learn about his recent article on platelet storage conditions, both cold-stored and roomtemperature, and how these conditions may impact the efficacy of platelets for certain uses.
Tell me about your study. What was it about and what were the main findings?
Cold-stored platelets were used back in the 1960s but their use was stopped because they were less effective for people who needed prophylactic transfusions; for example, those who have chronically low platelets due to chemotherapy. The problem with cold-stored platelets is that they don’t stick around in the patient’s body after you transfuse them. So, patients who needed prophylactic platelet transfusions would have to come back every single day, whereas with room-temperature platelets, these patients only require transfusions every three to four days.
Our study took another look at cold-stored platelets, as there have been interesting new reports in the literature indicating that cold-stored platelets are an effective short-term fix when it comes to people who are actively bleeding, like someone who has just experienced a traumatic injury or is undergoing childbirth complications1. The main finding of our study is that the in vitro storage characteristics of cold-stored platelets are very similar to what other investigators have found. They have better physiological responses, they aggregate better, and they can be stored for up to 14 days compared to the shorter 7-day shelf-life of room-temperature platelets.
In addition, we did a metabolomics study to help understand
what temperature does to platelet metabolites. When platelets clot in the body, they release all kinds of different metabolites, like lactate, or the antioxidant glutathione. We looked at approximately 200 metabolites and found that many are significantly affected by temperature. In the case of glutathione, we noticed that there is a consistent level of it in cold-stored platelets, whereas the room-temperature platelets consume glutathione very quickly. This suggests to us that roomtemperature platelets experience more oxidative stress, which may be why their storage quality isn’t as good as cold storage. There is much more work to be done with these metabolites, as many have distinct differences between cold and roomtemperature stored platelets — we’ve just scratched the surface.
What methods did you use to conduct the study? Why did you use these methods?
The platelet pools were generated by the buffy coat method by Canadian Blood Services, so the platelets that we used are the same as those used for transfusions in hospitals in Canada. Using the buffy coat method to generate platelets is different from what is done in the US, where they use apheresis platelets. Buffy coat platelets are generated from whole blood donations. To make one unit of platelet concentrate, you need to pool buffy coats from four donors together, whereas an apheresis platelet unit is from just one donor.
Many of the assays we used are standard and used throughout the world. We used hematology analyzers to measure platelet count, platelet volume, and other parameters such as blood gas, lactate content, glucose concentration, pCO2, pO2, calcium concentration, and etcetera. We also used flow cytometry to look at markers of platelet activation.
The metabolomics methods are a bit more complicated, so we collaborated with Angelo D’Alessandro’s group in Denver. They ran high-pressure liquid chromatography (HPLC) in tandem with their metabolomic machine. I’m not an expert on metabolomics, so it was very useful to have collaborators. The data analysis of the metabolic study was the most difficult part. You generate a lot of data with these studies so it’s difficult to sort out real differences versus the background.
Revisiting cold-stored platelets: An effort to improve patient care and storage
What is the biggest contribution of this study to the existing literature?
The biggest contribution would be the final figure of the paper where we link the in vitro study with our metabolomics study. Many groups have done the in vitro portion, and others have done the metabolomics, but what we really wanted to find out was how these metabolites affect in vitro changes in storage quality. To do that, we looked at the correlation between the metabolite changes and our in vitro work and we noticed that there were a couple of important pathways that impact storage quality.
One of the pathways that I mentioned before was the reactive oxygen pathway. This pathway is very important because it seems that when the platelets are being stored, they experience a lot of oxidative stress, especially platelets stored at room temperature. At room temperature the platelets are active, so they make a lot of free radicals, and thus they experience a lot of oxidative stress. Another key pathway is the pentose phosphate pathway. We saw that this pathway is highly activated in room temperature, but not cold-stored platelets. This gave us a good indication of which pathways are important when it comes to storage. We also looked at the platelets and how they clot using rotational thromboelastometry (ROTEM). We noticed that ADP and ATP are important for clot strength. This is somewhat expected because platelets need energy from ATP to do their work, so that’s another important pathway that we looked at.
What are the limitations of this study? How might the limitations be addressed in a future project?
One of the limitations of our study was suggested by one of the reviewers of the manuscript. The buffy coat platelets that we analyzed are stored in plasma. This brings up a limitation as we are unable to tell whether the metabolites we looked at came from platelets or from the plasma. From a purely scientific point of view, identifying plasma- versus platelet-derived metabolites is an important distinction that we didn’t address, but fortunately the goal of our study was to address what happens in platelet units that are used for transfusion in Canada, which are stored in plasma. Another limitation is that we do not know whether the metabolites came from inside the platelets, or if they were released from the platelets into solution. To add to that, we don’t know if the metabolites came from the organelles or the cytoplasm. These distinctions are very important, take the tricarboxylic acid (TCA) cycle for example, if we see a lot of TCA metabolites in the cytosol then that indicates that the mitochondria are failing. We don’t know the orientation or the origin of the metabolites we looked at, so it’s hard to make conclusions about such things as mitochondrial failure.
What are the future directions for this project?
Next, we will be focusing on the different pathways I mentioned previously. The ultimate goal of this project is to see if we can improve platelet storage in some way and I think this metabolomics study opened up a lot of different directions. We are now looking into inhibiting the pentose phosphate pathway to see if this prevents activation in both cold and roomtemperature platelets, which will further support our hypothesis that this pathway is important in storage. Beyond that, we will take advantage of the pathway to see if we can improve platelet storage quality.
If you were in a decision-making position within a blood organization, how would you store platelets?
The first thing I would do is run a clinical trial. Let’s assume the clinical trial is successful and Health Canada agrees that coldstored platelets are useful. I would then set up a dual inventory system of platelets for transfusion. We won’t be transitioning back fully to cold-stored platelets, as 70% of people needing a transfusion are those with a chronic need for platelets who will continue to need room-temperature platelets. The dual system would be useful since cold-stored platelets can be used for people who come in with traumatic injuries and active bleeding episodes since these are the patient who may benefit from cold-stored platelets. The other benefit is that the cold-stored product would be able to be stored for twice as long as room temperature-stored platelets. This would drastically increase platelet shelf-life for this part of the inventory. Additionally, remote hospitals in the interior or the northern parts of the provinces could have coldstored platelets on the shelf, which could help with the logistical challenges and costs associated with ensuring these hospitals can provide platelets to patients.
What is the take-home message of your work?
We are revitalizing an old product to improve patient care.
How did you feel after the experiments were done and the manuscript was complete?
After the experiments were done, I felt relieved, but to be honest after the manuscript was complete, I was really worried. At the time we submitted our manuscript, the COVID-19 pandemic was just beginning. A lot of the investigators were busy reviewing COVID-related papers, so our paper was sort of set aside. I didn’t feel fully relieved until the editor sent us the acceptance letter. C
Read the paper at: https://doi.org/10.1021/acs.jproteome.0c00792
1 Zhao, H. W., Serrano, K., Stefanoni, D., D’Alessandro, A., & Devine, D. V. (2021). In vitro characterization and metabolomic analysis of cold-stored platelets. Journal of Proteome Research, 20(5), 2251-2265. https://doi. org/10.1021/acs.jproteome.0c00792

Fibrinogen plays multi-faceted roles in many processes that are essential for the maintenance of human health and the prevention of disease1. The formation of a stable blood clot, for example, relies on thrombin-mediated cleavage of fibrinogen to fibrin1. On the flip side, elevated fibrinogen during inflammation (hyperfibrinogenemia) increases the risk of thrombosis2. Whereas extravascular fibrin(ogen) deposits at sites of tissue damage contribute to leukocyte recruitment and tissue repair3, the immunomodulatory activity of fibrin(ogen) may increase the metastatic potential of circulating tumour cells4. As such, strategies to fine-tune plasma concentrations of fibrinogen safely and effectively could have therapeutic utility1, 5
In a recent study published by the Kastrup Lab at the UBC Centre for Blood Research and Michael Smith Laboratories5, the authors investigated a strategy to modulate fibrinogen expression using lipid nanoparticle (LNP) delivery of small interfering RNA (siRNA) targeting the fibrinogen alpha chain (siFga) (Figure 1). Lead author Lih Jiin Juang and colleagues describe how dose- and time-dependent control of fibrinogen levels can suppress fibrin(ogen)-driven pathologies in various disease models.
Although strategies for decreasing circulating fibrinogen have been investigated, strategies to safely and durably decrease fibrinogen concentrations do not
exist. In the present study, administration of LNP-siFga to mice reduced liver Fga mRNA levels and fibrinogen levels in platelets and plasma. A dose-dependent decrease of fibrinogen in plasma was observed, with slowest recovery of fibrinogen levels at the highest dose. All levels returned to baseline after four weeks enabling the study of a range of fibrinogen levels over time.
Although the majority of the work in this study involved controlled knockdown of mouse Fga mRNA, human-specific LNPsiFga also successfully supressed FGA mRNA in a human liver cell line.

Furthermore, the authors investigated the effects of LNP-siFga administration on hemostasis using thromboelastography (TEG) to measure the stiffness of blood clots and mouse models of bleeding. Consistent with impaired hemostasis, the rate of clot formation and clot strength were significantly decreased in blood from siFgatreated mice. However, in mouse bleeding models, bleeding time and blood loss did not differ between siFga-treated or control mice, suggesting the impairment of hemostasis came with minimal bleeding risk.
Juang and colleagues then used three mouse models of disease to investigate the impact of LNP-siFga on fibrin(ogen)driven pathologies. These included an endotoxemia (lipopolysaccharides-induced), peritonitis (thioglycollate-induced), and experimental lung cancer metastasis model. Beneficial outcomes of LNP-siFga administration were observed for all three
models. In the endotoxemia model, for example, siFga administration attenuated hyperfibrinogenemia and markers of the acute phase response (a prelude to sepsis). Notably, in the lung cancer metastasis model, LNP-siFga treatment inhibited the metastatic potential of tumor cells to an extent comparable to that observed in fibrinogen-deficient mice.
Overall, the results of this study demonstrate the utility of LNP-encapsulated siFga as an experimental tool to investigate the role of fibrin(ogen) in a variety of fibrinogen-dependent processes. This method is considered a promising therapeutic strategy to manage fibrin(ogen)dependent pathologies, although further work is needed to establish its clinical utility.
An article related to the Kastrup Lab’s study has been published in the journal Blood: “When fibrin(ogen) is too loud, silence it!”6 C
Read the paper at: https://doi.org/10.1182/blood.2021014559
Vilar, R., Fish, R. J., Casini, A., & Neerman-Arbez, M. (2020). Fibrin(ogen) in human disease: both friend and foe. Haematologica 105(2), 284–296. https://doi. org/10.3324/haematol.2019.236901
2 Machlus, K. R., Cardenas, J. C., Church, F. C., & Wolberg, A. S. (2011). Causal relationship between hyperfibrinogenemia, thrombosis, and resistance to thrombolysis in mice. Blood 117(18), 4953–4963. https://doi.org/10.1182/ blood-2010-11-316885
3 Luyendyk, J. P., Schoenecker, J. G., & Flick, M. J. (2019). The multifaceted role of fibrinogen in tissue injury and inflammation. Blood, 133(6), 511–520. https://doi. org/10.1182/blood-2018-07-818211
4 Palumbo J. S., et. al. (2000). Fibrinogen is an important determinant of the metastatic potential of circulating tumor cells. Blood, 96(10), 3302-3309. https:// doi.org/10.1182/blood.V96.10.3302
5 Juang, L. J., et al. (2022). Suppression of fibrin(ogen)-driven pathologies in disease models through controlled knockdown by lipid nanoparticle delivery of siRNA. Blood, 139(9), 1302–1311. https://doi.org/10.1182/blood.2021014559
6 Neerman-Arbez, M. (2022). When fibrin(ogen) is too loud, silence it. Blood, 139(9), 1261-1262. https://doi.org/10.1182/blood.2021015215
Researchers at the UBC Centre for Blood Research (CBR) have made a significant advancement in how to check the quality of red blood cells for transfusion. They identified a practical and efficient method to help assess the quality of red blood cells (RBCs) in stored bags, without wasting bags during the testing process. Emel Islamzada, the first author of a recent paper on this subject and a PhD Candidate in UBC’s Multi-Scale Design Laboratory, talked to us about her work.
During blood donation, a donor’s blood is captured in two different areas: the blood bag and a length of tubing called the segment (Figure 1). The blood from the bag will be transfused into a patient while the blood from the segment will not. To check a blood bag’s quality, it’s possible to directly sample blood from the bag, but this method can waste or contaminate the entire unit. Instead, healthcare providers could sample blood from the bag’s segment to assess quality. However, this comes with another problem: RBCs degrade at different rates in segments and in bags, so it was unknown if the blood in these two areas had similar properties.
This is where Emel and her colleagues stepped in. In their recent study published
in Transfusion, they tried to confirm if the deformability of blood in the segment was similar to the properties of blood in the bag1

If so, a viable, non-wasteful option to test for blood quality could be simply to sample blood from the segment.
To assess blood quality in both the bag and segment, they looked at a biomarker called deformability. Deformability is a red blood cell’s ability to squeeze and change shape crucial for its job, where it must squeeze through tiny blood vessels while delivering oxygen throughout the body. The longer that donated RBCs are stored, the less deformable and more rigid they become, making them less useful to the transfusion recipient.
An RBC’s rigidity, or lack of deformability, could therefore be useful in assessing the quality of donated RBCs. Emel argues that RBC rigidity has been used as a highly sensitive biomarker for malaria infection, which contributed to her lab’s idea to measure it in this study.

The device used to test rigidity, called a microfluidic ratchet, was not commercially available (Figure 2). To tackle this issue, the engineers in Emel’s lab designed this device, and Emel was responsible for making them. She says, “I’ve been doing a lot of the bench work. Our devices are single-use, so I make them all from scratch. Then, I run the assays and analyze the data.”
Using this device, Emel tested and compared the deformability of the RBCs from the blood bag and the segment every 2 weeks up to 8 weeks. She found that the RBCs from the blood bag and the segment have similar deformability across all samples and all timepoints.
Through their work, the researchers confirmed that the deformability of RBCs are similar in both the segment and bag over time2, suggesting that it’s sufficient to sample from segments to check blood bag quality.
Despite the major engineering breakthrough, more research is still required before Emel and her colleagues can bring their product into clinics. They are unsure if the rigidity of the RBCs is an accurate representation of the overall quality of these RBCs in human. Animal and clinical studies are currently ongoing to answer this question. However, Emel is optimistic, and she expects that the rigidity test will be used in addition to current biochemical tests in the future, which could help healthcare providers to transfuse the RBCs of the best quality to sensitive transfusion patients.
We asked Emel about how she and her colleagues felt when this work was published. She says, “We are quite proud to contribute to this research area. There are still burning questions for us to answer, and we still need reliable, robust, and relatively easy ways to check for the quality of the red blood cells. But when you look at the amount of work that has been done to ensure that transfusions are as safe and effective as possible, it’s very humbling to be a part of it.”
C
Read the paper at: https://doi.org/10.1182/blood-2019-126090
Islamzada, E., Matthews, K., Guo, Q., Santoso, A., Scott, M. D., &; Ma, H. (2019). Deformability based sorting of stored red blood cells reveals donor-dependent aging curves. Lab on a Chip, 2(2), 226-235. https://doi. org/10.1182/blood-2019-126090
2 Islamzada, E., Matthews, K., Lamoureux, E., Duffy, S. P., Scott, M. D., & Ma, H. (2022). Blood unit segments accurately represent the biophysical properties of red blood cells in blood bags but not hemolysis. Transfusion (Philadelphia, Pa.), 62(2), 448-456. https://doi.org/10.1111/trf.16757
“Squeeze-ability” of
red blood cell: The deformability of red blood cells is a useful biomarker for storageFigure 1. An RBC blood bag, with segment tubing in front Figure 2. The microfluidic device used for rigidity assay. The image was captured under a microscope. The figure was adapted from Islamzada et al., 2021 1
 BY MARIE-SOLEIL SMITH, PHD CANDIDATE, CÔTÉ LAB & NANCY YANG, MSC STUDENT, CÔTÉ LAB
BY MARIE-SOLEIL SMITH, PHD CANDIDATE, CÔTÉ LAB & NANCY YANG, MSC STUDENT, CÔTÉ LAB
On April 6, 2022, the 11th annual Norman Bethune Symposium returned to UBC Robson Square, in its first-ever hybrid format since the beginning of the COVID-19 pandemic. The symposium honours Dr. Norman Bethune, a pioneer in the field of blood transfusion during the Spanish Civil War. This year, the hard-working team at the Centre for Blood Research (CBR) used two different platforms to allow in-person and virtual attendees to engage with speakers and poster presenters.
The symposium was packed with talks from celebrated international and local scientists, clinicians, trainees, and a moving patient testimonial. All speakers eagerly highlighted recent transfusionrelated research, with a special theme of personalized medicine recurring throughout the talks.
Dr. Dana Devine, CBR Director and Chief Scientist at Canadian Blood Services, delivered the opening remarks. She highlighted Dr. Bethune’s scientific contributions, his involvement with the Communist Party of Canada, and his eventual travels to China, with such an
eminent status that Mao wrote a poem about him.
Following the introduction, two international speakers shared their research. First, Dr. Andreas Greinacher from Greifswald, Germany, spoke about cases of COVID-19 vaccine-induced thrombotic thrombocytopenia in young people. He investigated vaccine components that could be involved, fueling a vibrant question period, no doubt due to the present-day relevance and implications of his work.
Next, Dr. Jeanne Hendrickson, Director of Transfusion Medicine at Yale University School of Medicine, talked about her work on red blood cell (RBC) alloantibodies, particularly among people with a higher transfusion burden, like those living with sickle cell disease. She was the first speaker to introduce a soonto-be recurring theme: the benefits of personalized medicine. Dr. Hendrickson emphasized that standard screening panels could be inadequate depending on the donor population, and that safer transfusions require representative panels. She also discussed how the dangers of RBC alloantibodies could be greatly reduced by developing a US-wide RBC antibody registry, and cited an existing, successful registry in the Netherlands that
is believed to have improved transfusion safety by 50%.
Right before the end of the first session, six poster presenter trainees went on stage to give fun, succinct “elevator pitches” that enticed the audience to visit their posters during the breaks.
Following the snack and poster break, three UBC trainees presented their research. First, Helen Chen discussed her work to develop a hydrophilic polymer coating for platelet bags, to prevent bacterial growth and improve transfusion safety. Next, Steven Jiang presented on the role of platelet signaling in rheumatoid arthritis, an autoimmune disease characterized by the role of fibroblastlike synoviocytes. Then, Massimo Cau introduced “Counterflow”, a technology developed by the Kastrup Lab to manage severe bleeding that, in their recent study, increased survival compared to fluid resuscitation in a swine model of noncompressible truncal hemorrhage.
Dr. Angelo D’Alessandro from the University of Colorado and Dr. Hongshen Ma from our very own UBC then both gave talks about RBC storage issues, reiterating
the need for personalized medicine. Dr. D’Alessandro highlighted that blood, like people, may age differently, and thus not all RBCs will age the same in a blood bag. He discussed how donor habits such as smoking, drinking, diet, and drug use can impact stored RBC quality. Dr. Ma similarly highlighted need to predict RBC circulation time, using deformability — as measured by a microfluidic ratchet device — as a proxy. There are differences between donors and their blood units, which again could allow for some degree of personalized medicine in patientspecific allocation of transfusion blood.
After lunch, we were treated to three more trainee talks. Erik Lamoureux’s talk provided an important machine learning angle to the RBC deformability project introduced by his supervisor, Dr. Ma. Next, we heard from Dr. Narges Hadjesfandiari of the Devine Lab, who highlighted the importance of considering blood donor proximity to heavy metal mines and donor age prior to transfusion. Elevated levels of heavy metals like lead in donor blood are problematic, and especially so if transfused into infants. The final trainee, Ashley Clarke from Dr. Prism Schneider’s lab at the University of Calgary, discussed the role of major orthopedic fractures and the associated increased risk of blood clots.
While the next four speakers covered a variety of topics, they emphasized a central theme: the clinical relevance of personalized medicine. Dr. Mark Yazer from the University of Pittsburgh discussed the necessity of pre-hospital transfusions to save lives following an accident. He introduced low titre group O whole blood as a means to provide balanced resuscitation very quickly while waiting for follow-up personalized transfusion. Following this discussion, Dr. Maureen Hoffman from Duke University discussed the pros and cons of using emicizumab as a treatment for hemophilia A. This disorder is characterized by factor VIII deficiency that can be treated with either a bypassing agent or the novel non-FVIII therapy emicizumab. Although this novel therapy acts similarly to FVIII, a small
sample has indicated a possible association between emicizumab and thrombotic microangiopathy.
Next, we heard from Dr. Mark Belletrutti from the BC Children’s Hospital. Dr. Belletrutti brought attention to the vast amount of platelet research that has occurred in Canada over the past ~40 years and highlighted rare platelet disorders such as the Quebec Platelet Disorder and Glanzamann Thrombasthenia. The last presenter of the session, Dr. Alexis Turgeon from Université Laval, presented results from the REMAP-CAP trial on the use of COVID-19 convalescent plasma in hospitalized patients. There was no effect of convalescent plasma compared to controls, but he hypothesized that a suboptimal product, wrong timing of product administration, or wrong populations could potentially explain the findings. He concluded by describing the next REMAPCAP arm with a more targeted approach, using high titre convalescent plasma from vaccinated donors in immunocompromised patients who respond poorly to vaccination.
The last set of talks was presented by another group of outstanding trainees. Dr. Sylvia Ighem Chi from Canadian Blood Services discussed identifying S. aureus exotoxins as a potential biomarker for bacterial contamination, to prevent the transfusion of infected products. She demonstrated how whole genome sequencing, RNA-seq, RT-qPCR, and protein identification can all be used to identify contaminated products. Roger Kou, an undergraduate from McMaster University, presented his findings from a systematic review on transfusion strategies for myocardial infarction. The last speaker, Dipon Saha from Dr. Dieter Bromme’s lab, discussed the use of a salvia miltiorrhiza (red sage)-derived inhibitor in the context of SARS-CoV-2 infection.
Dr. Erica Harris, a patient speaker, concluded the talks by sharing her miraculous health journey. Throughout her leukemia diagnosis, unsuccessful chemotherapy, terminal 2-month lifeexpectancy prognosis, spontaneous
remission, lung transplant, and subsequent life-threatening infections, her will to live remains strong and unwavering. If you want to hear more from this incredible woman, check out the Rise Today Inspirational podcast.
The day drew to an end with the best poster award presented to two trainees. Congratulations to Lisa Yamaura for her virtual poster investigating platelet contribution to hypercoagulability in patients with metastatic bone disease, and Pranav Shrestha for his in-person poster investigating the low-cost screening of sickle cell disease and ß-thalassaemia in Nepal.
We would like to say a big thank you to the sponsors of the event as well as to the organizers, speakers, and attendees who all played a vital role in the success of the event, as we slowly begin to reintroduce in-person conferences.
The Centre for Blood Research would like to thank our event sponsors, without whom the 11th Norman Bethune Symposium would not have been possible: Pfizer, the Naiman-Vickars Endowment Fund, Bayer, the Canadian Blood Services, and GRIFOLS. C

 BY MELODY WENG, CBR SUMMER STUDENT ALUM, TIEN DO, CBR SUMMER STUDENT ALUM & CHRISTINA PAN, CBR SUMMER STUDENT ALUM
BY MELODY WENG, CBR SUMMER STUDENT ALUM, TIEN DO, CBR SUMMER STUDENT ALUM & CHRISTINA PAN, CBR SUMMER STUDENT ALUM
Over the COVID-19 pandemic, the number of active blood donors dropped by 37,000 across the country, leaving Canada at its lowest donor number in a decade1. This not only creates a blood shortage crisis for patients in clinics, but also leads to a lack of biomaterials for scientists conducting blood research.
The netCAD Blood4Research Facility helps provide these important biomaterials and blood sources for important research. What exactly is netCAD? Part of the Canadian Blood Services Medical Affairs and Innovation division, it is located at the University of British Columbia (UBC), and produces high quality and prepared blood products for scientists and research institutions.
On August 9th, 2022, our cohort of 12 Centre for Blood Research (CBR) summer students toured the netCAD
Blood4Research Facility, to learn more about what they do and how their work benefits scientists and patients alike.
Guided by Le Lam, an experienced coordinator, and Emmanuel Zurbano, a Development Assistant of over 10 years of lab experience, the facility staff showed us the detailed blood storage process, and how blood components are separated for research purposes. Specifically, they showed us how whole blood — which contains red blood cells, white blood cells, plasma and platelets — is separated into its different components. They also demonstrated how they test for bacterial contaminants in blood, to continue keeping our blood supply safe.

First, the staff placed blood products in a centrifuge. This allowed the blood to separate into layers: heavier hematocrit at the bottom, with platelets (in a buffy coat) on top, and plasma near the top of the blood bag. Using a blood component extractor, the red blood cells, platelet buffy-coat, and plasma are then separated into three different bags.
Four buffy coat bags from different donors are then connected in a chain, to create what is called a pooled buffy coat. After the pooled buffy coat is centrifuged, the platelets reside in the top layer and residual red blood cells are at the bottom. The platelets are then extracted through a filter to remove white blood cells, and the residual red blood cells are discarded.
Generally, whole blood must be processed into individual components within 1 to 3 days, depending on the components being produced and the temperature during processing. Red blood cells have a shelf-life around 42 days, while platelets can only last for 5 to 7 days before they have to be discarded2. This is why blood separation is crucial: it not only provides us with different blood products for different uses, but also lets us follow storage safety guidelines that are specific to each component.
Next, we learned about bacT testing, a process where platelets are tested for active bacterial contaminants. It’s an important aspect of quality control and ensuring patient safety, and is conducted on an as-needed basis for research. Platelets that undergo bacT testing are used in hospital settings, while the other blood products in the netCAD facility are prepared for research purposes.
We also observed another blood donation process, called apheresis, in real time. Unlike whole blood donation, where all components of your blood are collected and later separated, only specific blood components are collected during apheresis thanks to a special instrument used for apheresis, located in the donation clinic!
From this trip, we learned about the intricate processes behind blood donation, how blood is separated into different components, and different ways that you
can donate blood products. We also learned how donating blood for research differs from donating blood for clinical use; the first has fewer restrictions on who can be a donor, whereas the latter has stricter requirements because it is more focused on patient safety. This educational trip taught us so much about blood donations for research, and also about the importance of blood donations on a broader scale.
We would like to extend a big thank you to Dr. Peter Schubert, Le Lam, Emmanuel Zurbano, and all the netCAD staff, as well as Dr. Dana Devine, CBR Director, and Dr. Parvin Bolourani, CBR Education Program Manager, for this opportunity! C
Alhmidi,
19, 2022, from https://www. nationalobserver.com/2022/08/09/news/canadian-blood-servicescallout-donors-collection-challenges
2 Blood components. Plasma, Platelets and Whole Blood | Red Cross Blood Services. (n.d.). Retrieved August 19, 2022, from https://www. redcrossblood.org/donate-blood/how-to-donate/types-of-blooddonations/blood-components.html

PANIZ GHAVIMI, 2022 UNDERGRADUATE SUMMER STUDENT

Project: Development of antiinflammatory coatings for biomedical devices
Supervisor: Dr. Ed Conway
The CBR Summer Studentship Program was a great opportunity where I had a chance to be part of the wonderful CBR community and an amazing research lab. I was mentored by incredible people more specifically by Kevin Gonzalez and Dr. Edward Conway, where I learned various techniques and gained valuable lab and research experience. Additionally, during this program, I had a chance to participate in many helpful synergy workshops, the CBR Summer Seminars, socials, and Research Day. The Research Day provided an opportunity for me and other summer students to practice our science communication skills, present our summer research, and learn about each other’s projects. Overall, the CBR Summer Studentship was an absolutely wonderful program, and I feel so lucky that I was able to be part of it. I am so grateful for my mentors, the program coordinators Parvin, Danielle, Jocelyn, and the CBR community. I am looking forward to future CBR opportunities. C


MELODY WENG, 2022 UNDERGRADUATE SUMMER STUDENT
Project: Evaluating the effects of calcium flashers on increasing calcium administration rates and improving markers of blood coagulation
Supervisor(s)/Collaborator(s): Mina Salehi, Xiu Qing Wang, Kanwal Deoh, Sakara Hutspardol, Jian Mi, Phillip Dawe, Dr. Andrew Shih
This summer in the CBR-SBME Summer Studentship Program, I had the honour of working on a project investigating the efficacy of the current calcium administration system at Vancouver General Hospital, and how it improves trauma patient outcomes. This project is needed because when trauma patients receive large amounts of blood products via transfusion, components in bagged blood actually bind to their blood’s calcium stores, causing hypocalcemia and reducing their blood’s coagulative ability-along with other physiological risks. Thus, the VGH trauma department is testing the efficacy of a new “Calcium Flasher” system, which consists of reminders in packs of blood products used in massive transfusions that remind physicians to administer extra calcium whenever blood products are given. This system aims to reduce hypocalcemia, improve hemostasis, and improve trauma patient outcomes.
I am grateful for this opportunity to work with physicians and medical residents in improving the quality of preventative medicine, as well as to participate in professional development workshops and make new friends to enjoy my summer with. After my time in this program, I am more ready than ever for a career in healthcare leadership and to participate in future clinical research. Special thanks for Dr. Parvin Bolourani for being such a kind, supportive program coordinator and making this summer an absolute blast! And shoutout to Dr. Andrew Shih for being a knowledgeable and supportive supervisor. Wouldn’t have made it this far without you guys! C
Read more summer student stories and meet the cohort at: www.tinyurl.com/cbrsummerstudentshipprogram
The CBR was so pleased to host its first small, in-person social in 2 years!
The CBR Summer Social welcomed undergraduates from this year’s Summer Studentship Program, celebrated new CBR alumni, and commemorated the end of the academic year for the Graduate Award Program (GAP) cohort.


This small gathering allowed CBR members from different labs and research groups to meet each other and catch up over a delicious selection of drink and tasty food.

The CBR Health & Wellness Committee held a photo contest over the summer months with 3 themes: scenery and outdoors (inanimate), pets and wildlife, and CBR members.
We received 98 photo submissions, and the top 3 choices were determined through voting by the CBR community:
1. Peter Bell, Overall Lab
2. Georgina Butler, Overall Lab
3. Dr. Christopher Overall, Overall Lab
It was wonderful to catch up in-person, meet new CBR members, welcome returning members, and celebrate the start of the new term! This small gathering allowed CBR members, old and new, to socialize over coffee and treats.
Dr. Vogt shared some insightful takeaways with our audience:
1. If you love doing cutting-edge research and working with a supportive team, a career in industry may be a great fit for you!
2. Don’t feel constrained by the subject matter of your degree. As long as you have the appropriate core skills and can show that you are a quick learner, many employers are willing to provide on-the-job technical training.
3. Connections that you’ve made through your graduate studies, are great resources when you’re thinking about your next career steps.
For any questions about the Career “Ask Me Anything” (AMA) Café series, contact the CBR’s Education Program Manager, Dr. Parvin Bolourani at: parvin@mail.ubc.ca.

National Postdoc Appreciation Week (NPAW) 2022: CBR Lunch
Sept 22 | LSC Pod
National Postdoc Appreciation Week (NPAW) recognizes the significant contributions that postdoctoral scholars make to research and discovery, with NPAW 2022 taking place from September 19 – 23.
The CBR held a social for everyone to meet Postdocs and Research associates at the CBR, and to recognize their wonderful commitment in making the Centre outstanding.


For people to get to know each other, the CBR also held a game where attendees could fill out a get-to-know-you sheet to be entered into a raffle draw! Congratulations to the raffle winners: Alexandra Witt and Peyman Malek Mohammadi!
CBR Fall Door Decorating Competition: Pizza & Pumpkin Pie Social
Oct 28 | LSC Pod
To celebrate the spooky season, the CBR Health & Wellness Committee organized a fallthemed door decoration contest, along with a Pizza & Pumpkin Pie Social.

CBR labs were encouraged to decorate their lab door or space, and members voted for the winners at the social event. Thank you to everyone who attended, and congratulations to the winners (left to right):
1st Place: Brömme Lab
2nd Place: Devine Lab
3rd Place: Côté Lab
Career Ask Me Anything (AMA) Café: Dr. Cyrus Eduljee,

Oct 27 | Zoom
Dr. Eduljee shared some insightful takeaways with our audience:
1. Do not underestimate your life sciences background! A strong scientific background is extremely beneficial for many positions in commercial, government and non-profit roles due to its highly specialized knowledge requirements.
2. The growth in scientific research and knowledge has created a commensurate increase in the roles and jobs needed to translate this knowledge into products, policies, and services that serve the public good.
3. The number and types of positions available to graduates outside of academia are dynamic and continue to evolve as new industries and applications are developed.
Read about more events and activities at: www.cbr.ubc.ca/category/news/events/
 BY WARIS BHATIA, CBR SUMMER STUDENT ALUM & PANIZ GHAVIMI, CBR SUMMER STUDENT ALUM
BY WARIS BHATIA, CBR SUMMER STUDENT ALUM & PANIZ GHAVIMI, CBR SUMMER STUDENT ALUM
Want to learn about the latest research at the Centre for Blood Research (CBR)? If cutting-edge, interdisciplinary work in science and medicine interests you, then you’ll want to catch this event recap on CBR Research Day 2022!

The CBR’s community and friends gathered in-person for CBR Research Day on August 16th, to celebrate the achievements of summer students in the CBR Summer Studentship Program. The Program provides undergraduate students with the opportunity to gain hands-on research experience, and to take part in professional development workshops on topics like time management and career development. As the event was held online for the past 2 years, it was refreshing to see posters and attendees in the Life Sciences Centre Atrium!
After a delicious lunch, the event began with brief remarks from the CBR Director, Dr. Dana Devine. This was followed by oral talks from the summer students, who all did an amazing job presenting their research with short, 3-minute presentations.
Following the talks, Dr. Devine announced
the winner of the Neil Mackenzie Mentorship Excellence Award. This award honours the memory of Dr. Neil Mackenzie, a late Postdoctoral Fellow in Dr. Dieter Brömme’s lab, who was a caring and dedicated mentor to his students and colleagues.
Dr. Samantha Grist, a Postdoctoral Fellow in Dr. Karen Cheung’s lab, received this year’s award. In her acceptance speech, she expressed how her own mentors were critical in helping her overcome obstacles, and pointed out the importance of having mentors to guide you through your career. Congratulations to Dr. Grist and the other nominees, and thank you for providing a nurturing environment at the CBR!
Next, Dr. Anna Blakney gave an enlightening presentation about next-generation RNA vaccines and therapies. Dr. Blakney explained how her lab developed a vaccine for SARSCoV-2 in an impressive timeline of just 6 months, and how mRNA technology can be applied to a novel pathogen.
The second half of CBR Research Day continued with poster presentations by summer students, who chatted with attendees

about their projects, and showcased their three-month research journeys through the Program. Many also engaged with graduate students and judges about their future plans.
Before the end of the event, Dr. Dana Devine announced the student presentation awards:
• Best Oral Presentation: Melody Weng, from Dr. Andrew Shih’s lab

• Best Poster Presentation: Tien Do, from Dr. Robert EW Hancock’s lab
• People’s Choice Award: Sofia Levy, from Dr. Hélène Côté’s lab
Congratulations to all! When asked about their experience, each awardee shared something different. Melody said that she was thankful for the opportunity to dip her toes in clinical research this summer through the Program, and that she looks forward to future CBR opportunities and broadening her research interests.
Tien expressed her immense gratitude for being able to have her own project, and showcasing it to researchers and graduate students in the field.
“The poster presentation was my favourite part of the event,” she added. “Not only did I enhance my presentation skills by conveying a research story to other people, but I was also able to design and organize my data to put on a poster.”
Sofia shared she was honoured to have received a presentation award, and that it’s great that the Côté Lab’s research resonated with the audience. She also aims to continue learning about actionable ways to improve healthy aging of women living with HIV.



Lastly, the day concluded with a lovely dinner and delightful socializing amongst the attendees.
We would like to greatly thank all the amazing sponsors, enthusiastic volunteers and supporters of the CBR. Additionally, we would like to acknowledge the CBR Summer Studentship Program, which provided undergraduate students with this incredible opportunity, and Dr. Parvin Bolourani, the CBR Education Program Manager, for amazingly organizing the workshops and supporting the students during this period and beyond.
Look forward to learning more about the outstanding research done at CBR, and see you again next year!
Many thanks to our sponsors, without whom the CBR Summer Studentship Program and CBR Research Day would not be possible: the Neil Mackenzie Memorial Fund, the Naiman-Vickars Endowment Fund, Bayer, the Canadian Blood Services, Stago and GRIFOLS. C
Learn more about the CBR Summer Studentship Program: www.tinyurl.com/ cbrsummerstudentshipprogram
Top: Summer students who presented oral talks gather for a group photo
Bottom left: Summer students, volunteers, and Dr. Parvin Bolourani, the CBR Education Program Manager, come together for a group photo.
Bottom middle: Collage of the CBR summer student cohort 2022





Bottom right: Summer students who won awards holding their award plaques. L – R: Sofia Levy, Melody Weng, Tien Do.




Mentorship is an integral part of the CBR and the CBR Summer Studentship Program. Each year, the CBR will recognize an individual who has demonstrated outstanding commitment to mentorship and the development of others, in memory of Dr. Neil Mackenzie, a late Postdoctoral Fellow in Dr. Brömme’s lab.

CBR members have the opportunity to nominate their mentors for the Neil Mackenzie Mentorship Excellence Award. The award recipient is announced at CBR Research Day in August.
We were so pleased to receive nominations for 16 individuals this year! Congratulations to all, and thank you for fostering a supportive learning environment at the CBR.
PhD
Mitacs Elevate Postdoctoral Fellow, BioMedical Micro Devices (BioMEMS) Lab (led by Dr. Karen Cheung)


2022 Neil Mackenzie Mentorship Excellence Award Recipient


Tell us about your research.
My work mainly focuses on delivering gene therapies, where we develop delivery platforms called liposomes and lipid nanoparticles. These are the same platforms used to carry mRNA for the COVID-19 mRNA vaccine. My research aims to maximize the treatment effectiveness of these lipid nanoparticles with different genetic cargos. I look at how these particles formulate, encapsulate RNAs, and deliver and disassemble in vitro and in vivo These are all fundamental mechanisms behind how lipid nanoparticles and gene delivery work. By understanding those principles, we can rationally design new formulations and particles to maximize their therapeutic efficacy.
How did you feel when you received the Michael John Page Postdoctoral Fellowship Award?
I honestly did not expect to be selected, but I felt incredibly honored and wanted to take this opportunity to share my passions and my love for science, along with my scientific journey, which I think echoes many others.
I started my career as a synthetic chemist but had many learning opportunities to tap into lots of different research areas. Eventually, I gathered many techniques and skills in biology, and formulation science. Those experiences had put me in a perfect position to dive into a new avenue of nanomedicine and gene therapy when I joined UBC last year. It was something that I wanted to share during my award lecture.

Science is a great way to explore the unknown, but it is also a powerful tool when we can combine basic scientific principles and apply them to real-life situations. I think UBC has done a great job of enabling this in the life sciences sector.
In particular, I fell in love with nanomedicine because I can utilize basic science as a tool to address fundamental questions, while applying these technologies to diagnose and treat various diseases and have a global impact. Given many recent advancements and clinical applications, it’s a very exciting time for the field of nanomedicine and I am lucky to be part of this.
I hope I can continue in nanomedicine research and pursue a scientific career path in either academia or industry.

I’m quite adventurous and like to try new activities – badminton aside, I also enjoy other outdoor and indoor activities such as camping and bouldering. I’m also really looking forward to skiing in the beautiful Whistler mountains this winter season!
The last thing I want to share is that it’s very inspirational to go into science. This award honours Michael and his science, and how he brought so much joy and passion to people who surrounded him for his research, personal life, and interests.
Doing research is no easy task; much like a rollercoaster, scientific research often means there are a lot of ups and downs. One thing that Michael demonstrated is that we all need to do this together: no one does research on their own. I’m incredibly honored and grateful to have met such wonderful people, and being able to make so many life-long friends throughout my scientific journey. C
Learn more about the award at: www.tinyurl.com/cbrmjppostdoctoralfellowaward
Top left: Dr. Miffy Hok Yan Cheng, a Postdoctoral Fellow in the Cullis Lab
Top right: Dr. Miffy Hok Yan Cheng hiking outdoors
Bottom: Dr. Miffy Hok Yan Cheng holding the Michael John Page Postdoctoral Fellow Award plaque


My name is Alexandra, and I am a graduate student in the Pryzdial lab developing a novel clot-busting drug by mutating coagulation factor X. The CBR Graduate Award Program was an opportunity for which I am very grateful. As a new trainee during a Zoom-based award year, I was really appreciative of the ability to meet peers in the CBR, some of whom have become very good friends. While in the GAP program, I have had the opportunity to participate in several journal clubs, career development workshops, and both in-person and online events.
At the end of the day, with a “this will be what you make of it” program, I think it’s safe to say that the 2021/22 cohort did a great job. We are so thankful to the CBR team who made this possible, and for all of our experiences throughout the year. C
Read about more GAP student stories at: www.tinyurl.com/cbrgraduateawardprogram

As a PhD candidate in Biochemistry and Molecular Biology at UBC in the Centre for Blood Research, my research interests include hemostasis, biomedical engineering and nanomedicines. I am currently working to genetically engineer platelets using lipid nanoparticle technology to enhance their function and hope to establish engineered platelets as a platform technology.
The graduate award program (GAP) has had a tremendous impact on my professional career development; helping me build the skills and personal network necessary for success in both my immediate research and career.
One of the more meaningful takeaways was the personal and professional relationships generated with other award holders and coordinators, especially considering that my participation in the program was in the pandemic era.
Ultimately, the opportunity to participate in the GAP has been invaluable to my PhD experience here at UBC. A big thank you for the opportunity to be part of this amazing program and to the coordinators Parvin and Dana for adapting to highly unique circumstances this year. C


research, media mentions & news articles



CBR scientists receive federal support to advance mRNA vaccine technologies
Dr. Natalie Strynadka and Dr. Leonard Foster have received $11.1 million for research on the delivery and efficacy of mRNA vaccines.
Research answers questions about infusion pumps’ effect on red blood cells


Dr. Narges Hadjesfandiari and Dr. Dana Devine are helping to answer questions about the effect of infusion pumps on red blood cells, making it easier to evaluate the safety of these pumps for this use.
2022 Health Innovation Funding Investment (HIFI) Awards from UBC Health
Members of the McNagny and Rossi labs received HIFI Awards, which enable interdisciplinary groups of health researchers to undertake innovative activities that have the potential to create change, catalyzing cross-faculty and cross-campus collaborations at the Vancouver and Okanagan campuses.
CBR researchers draw in more than $2.8M with CIHR Spring 2022 Project Grants
Dr. Hongshen Ma and Dr. Aly Karsan received funding, drawing in more than $2.8 million for research projects.

Dr. Agnes Lee: Thrombosis is a common complication in the cancer journey
For World Thrombosis Day, Dr. Agnes Lee shared her work and knowledge on understanding, preventing and treating venous thromboembolism, a dangerous complication that can occur with cancer.
Read about more research at: www.cbr.ubc.ca/category/news/research/
Read more media coverage at: www.cbr.ubc.ca/media-coverage/
love to communicate, but I get really nervous speaking in front of people. When I heard about the Three Minute Thesis at the start of my degree, my first reaction was like, ‘Oh, no.’ ”
Mopelola (Lola) Akinlaja faces a common dilemma: she loves sharing her science, but hates public speaking. This year, she challenged herself to take part in UBC Three Minute Thesis (3MT), where graduate students explain their thesis topic using one slide, in three minutes or less. She placed second in the competition, which featured over 28 UBC graduate students.
“I’m getting close to graduating, and if there’s anything grad school has taught me, it’s to challenge myself and push my limits, especially when I have a goal,” she said.
A chemist by training, Lola worked at an agrochemical company before graduate school, where she is now a fifth-year PhD student in the Foster Lab at the UBC Centre for Blood Research and Michael Smith Laboratories. Her research aims to understand how a pathogen called Nosema causes infection in the honeybee gut – specifically, how Nosema disrupts important protein interactions in the gut, leading to illness.
She approached the 3MT with the mindset that at best, she might win, and at worst, it would be a good learning opportunity. Reflecting on her experience, she emphasized the importance of personal growth from getting feedback after every 3MT heat, and from watching other students’ presentations.
“I thought I would be a little sad to come in second, but I was actually so happy, because all of the ten finalists’ talks were so, so good,” she said. “I was in awe of all the incredible projects going on at UBC. Hearing everyone’s passion and their analogies, seeing their slides, and being recognized as a winner among all these people you admire – it was just really gratifying.”
Though she still finds public speaking nerve-wracking, Lola emphasized that communicating to the public is an essential skill, one that every scientist should learn. She actually views science communication as more of a responsibility than a hobby, a perspective that helps her overcome her fears.
“I was that kid who always asked questions that people might think are ‘dumb’. But honestly, I don’t think that any question is too silly to ask,” she said. “I truly believe that anyone can understand any concept.”
Even in the span of her PhD, Lola said that there were certain concepts from her first year that she found difficult to understand – concepts that she can now explain with ease, several years later.
“Sometimes you just have to take extra care to explain something technical, and make it accessible to whoever your intended audiences are. That’s also the value of events like the 3MT, which help you practice that.”
Outside of the 3MT, Lola also shares her research with Grade 4 to Grade 12
students through outreach activities from the Michael Smith Laboratories, and was formerly a Community Scientist with Science World. She hopes to spark the interest of children and younger audiences, and to reach underserved communities who may face barriers to education, or be unaware of scientific opportunities.
Along with collecting and analyzing more data for her thesis, Lola’s plans include participating in more public speaking initiatives with diverse audiences, and to eventually launch a science communication page on Instagram.

“I’m really grateful that I’ve been surrounded by people who fostered my curiosity, and people I could ask questions to,” she said. “That motivates me to pay it forward and make science easier for others to understand, just as people have explained things to me.” C

Mopelola
wins second place in the UBC 3MT competition, encourages grad students to challenge themselves
We are happy to congratulate Nicolas Pereyra for placing in the top three of this year’s UBC Three Minute Thesis (3MT)!

The 3MT is an academic competition that challenges students to hone their presentation and communication skills, as participants only have 3 minutes to explain the breadth and impact of their research to a general audience. The competition is held at universities across the world, showcasing research and discoveries from health science to engineering.
This year, Nicolas presented his graduate research project on extending the shelf-life of blood products, by designing a coating that protects the cells inside these packages. Specifically, he is modifying platelet storage bags, which hold important and irreplaceable blood clotting factors.
“You can replace somebody’s heart and they will live. You can put people on dialysis or artificial lungs, but there is no replacement for blood products. That just doesn’t exist yet,” said Nicolas, a MSc Student in the Devine Lab. “Maintaining the quality of blood products is essential for anything that comes into contact with blood, from COVID vaccines to implantables and prosthetics.”
He was inspired to participate in the UBC 3MT due to his love for public speaking, and to share his work and dedication to science.
“The ability to explain something in a simple way — to people that don’t know
anything about science – is super valuable,” said Nicolas. “Public speaking skills are useful for communicating with anyone, from any discipline. You have to be able to speak the layman’s language, otherwise collaborative work becomes nigh impossible. You can’t live your whole life speaking in fancy acronyms when other people have wildly different educational backgrounds.”
Nicolas then affirmed the value of intercommunication between scientists and the general public. “You have a responsibility, at the end of the day, to communicate about the important and cool work that you do, to a world that doesn’t know what you’re doing.”
He also feels that science communication tools are not easily accessible to students, and hopes there are more readily available resources.
“I would love to do more science communication-type stuff like public speaking, but it’s tough,” he said. “Maybe a takeaway from this experience is trying to find a little hub where people can go to find all of the current opportunities for public speaking and communication, because I’m sure there’s interest for it.”
Although Nicolas tied for third, he’s got his eyes on first place and is ready to come back again next year. He plans to compete in several other pitch competitions as well. In the meanwhile, you can find Nicolas in Dr. Dana Devine’s laboratory as he continues to work on his research. Stay tuned! C

 BY RHONDA THYGESEN, MSC STUDENT, FOSTER LAB
BY RHONDA THYGESEN, MSC STUDENT, FOSTER LAB
This piece is part of the “Day in the Life of a Scientist” series, where Rhonda Thygesen uses photography and writing to give a unique lens into the daily lives of CBR researchers. In this piece, she covers the research of PhD student Abigal Chapman C
Read the full story at: www.tinyurl.com/cbrditlhoneybeescientist
Here’s a paradox: I am a medical student who dreads going to a new hospital. Why? Because inevitably I will get lost. Many other people are also anxious about going to a hospital. Beyond the association with illness, healthcare settings tend to be cold, unwelcoming, and confusing areas. But why?
This sister article to my previous piece on laboratory space design hopes to shed light on this often-overlooked aspect of healthcare: design. If you are skeptical about the effects of design on our wellbeing, then think about this: hospitals with more operating rooms have been shown to perform more Caesarean sections1. The way our buildings are structured quite literally could impact us from the day we are born.
Hospital architecture has changed dramatically over the course of 150 years. While it may be tempting to assume that these buildings are designed with an objective and utilitarian goal in mind, the culture and values of the people surrounding the hospital often have more sway on its design. Victorian hospitals were designed with ventilation in mind and were styled as half-and-half institution
and residence, whereas its antecedent, the interwar modern hospital, was focused much more on efficiency and thus crammed more utilities, rooms, and equipment into its allocated space2. The postwar modern hospital is the “classical” hospital design we think of with its white and sterile hallways2. But now, new postmodern hospitals have introduced more color and resemble airports or shopping malls in terms of aesthetics2. It will be interesting to see how hospitals continue to evolve in the next 150 years.
We’ve all been awoken from a deep slumber by an annoying roommate or sibling turning on a light. Now imagine you are in the intensive care unit (ICU) where there is a constant and bright light while you are desperately trying to stay alive. A phenomenon known as “ICU psychosis” has been observed in both adults and children and has been partially attributed to this constant and unnatural disruption to our circadian rhythm, especially during a time when sleep is most critical3-5
But bright lights are not all bad. As obvious as it may seem, having brighter lights in hospitals can prevent medical errors associated with visual tasks, such as dispensing medications6. Perhaps being mindful of where bright lights are necessary and where they can be dimmed
can go a long way towards creating a more comfortable environment for both patients and healthcare providers.
Although shows like House or General Hospital show plenty of solemn and quiet moments with patients and physicians, the reality is that hospitals are very loud places. So loud in fact, that most hospitals have higher noise levels (50-100 dB) than what is recommended by the World Health Organization (<35 dB)7. For context, 100 dB is the sound of a car horn or power tool. High noise levels may also contribute to the previously noted ICU psychosis3 ,4
And it’s not just patients feeling overstimulated: staff also report noiseinduced stress. So, what can be done? Simple solutions such as using soundabsorbing instead of sound-reflecting ceiling tiles can decrease noise levels and have been shown to improve the working conditions (and thus the healthcare provided) of hospitals8
Getting lost in a hospital may be one of the few truly universal human experiences. Hospitals are often very large and house many different departments, so an

intuitive wayfinding process is a necessity. It is important to not only be mindful of how landscape, interior architecture/ design, signage, graphics, and amenities can influence how easy it is to find a specific location, but also to incorporate many strategies so that everyone can find their way9, 10. For example, including maps and written instructions for cognitivelyfocused individuals, volunteers to guide/ talk to people for verbal communicators, and landmarks and colors for visual learners will make sure that fewer people are late to their appointments9 ,10
But getting lost and walking long distances are not problems only for patients. Nurses, who spend almost a third of their day walking, feel fatigue and stress because they must walk long distances from one task to the next3
Are there any real-world examples of intuitive wayfinding? This is where the principle of “progressive disclosure”9 becomes useful. This basically means that information is disclosed when needed instead of being given all at once. For example, your Google/Apple maps app doesn’t give you all the directions at once: rather it is given to you once you’ve reached a certain destination. Patients arriving at the hospital for the first time may find themselves overwhelmed with instructions, landmarks, and confusing corridors9 Instead, having a stepwise approach to wayfinding will make navigation much smoother and less stressful.
Finally, we arrive at the smallest but perhaps most intimate aspect of hospital design: the bedspace. There is overwhelming evidence that single rooms provide more benefit than multibedrooms: there is increased privacy, decreased noise11, less chance of spreading infection12, and more comfortable visits from families and loved ones. While sometimes a shared spaced is preferable (long-term elderly and pediatric patients can benefit from the company of others close by), having a private space for patients and their families is not only in keeping with a patient-centered approach to healthcare, but may also derive medical benefit as well: when families are involved in a patient’s healthcare, including discussion of medications and care plans, patient mortality decreases13. Isn’t that the ultimate goal of a place of healing – to simultaneously help the patient physically, mentally and emotionally?
With all this being said, does this mean we need to tear down all the hospitals built before 2022 and start again? Not at all. Instead, this means that we should take lessons and ideas that worked from the past, incorporate realistic and practical changes in the present, and be proactive and mindful in future hospital designs. As an example, St. Paul’s Hospital is undergoing redevelopment: check out their design page and see for yourself – they
are incorporating the elements discussed here. And most importantly, we must not forget that the role of a hospital is a place of healing! So, it must be designed with the health, comfort, and wellbeing of both patients and staff in mind. C
This blog is the second in a two-part series about the design of scientific spaces.
The first blog, focused on the design of laboratory spaces, was published in a previous magazine issue: “No Home for My Genome (Sequencing Apparatus): Special Considerations for Laboratory Design”.
1 (2017). Designing Capacity for High Value Healthcare: The Impact of Design on Clinical Care in Childbirth. MASS Design Group. https:// massdesigngroup.org/sites/default/files/file/2017/170223_Ariadne%20 Report_Final.pdf
2 Adams, A. (2016). Canadian hospital architecture: How we got here. CMAJ 188 (5): 370-371. https://www.cmaj.ca/content/188/5/370

3 Monks, RC. (1984). Intensive Care Unit Psychosis. Can Fam Physician 30: 383–388. https://www.ncbi.nlm.nih.gov/pmc/articles/PMC2154033/
4 Joseph A and Rashid M. (2007). The architecture of safety: Hospital design. Curr Opin Crit Care 13: 714–719.
5 Hughes J. (1994). Hallucinations following cardiac surgery in a pediatric intensive care unit. Intens Crit Care 10:209–211.
6 Buchanan TL et al. (1991). Illumination and errors in dispensing. Am J Hosp Pharmacy 48: 2137–2145.
7 Xyrichis A et al. (2018). Noise pollution in hospitals. BMJ 363: k4808. https://www.bmj.com/content/363/bmj.k4808
8 Blomkvist V et al. (2005). Acoustics and psychosocial environment in coronary intensive care. Occupat Environ Med 62: 1–8.
9 Huelat BJ. (2007). Wayfinding: Design for Understanding. The Center for Health Design. https://www.healthdesign.org/system/files/ WayfindingPositionPaper.pdf
10 Harper et al. Designing Wayfinding Systems for Hospitals (Poster). University of Houston Clear Lake. http://cms.hfes.org/Cms/media/ CmsImages/Designing-Wayfinding-Systems-for-Hospitals.pdf
11 Ulrich RS. (2006). Evidence-based health-care architecture. Lancet 368: S38–S39. https://www.thelancet.com/pdfs/journals/lancet/PIIS01406736(06)69921-2.pdf
12 Stall N. (2012). Private rooms: evidence-based design in hospitals. CMAJ 184: 162-3. https://doi.org/10.1503/cmaj.109-4079
13 Kuipers SJ et al. (2019). The importance of patient-centered care and co-creation of care for satisfaction with care and physical and social wellbeing of patients with multi-morbidity in the primary care setting. BMC Health Serv Res 19 https://doi.org/10.1186/s12913-018-3818-y
For National Postdoc Appreciation Week (NPAW), we spoke with several Centre for Blood Research (CBR) Postdoctoral Fellows and Research Associates, to highlight their work, celebrate their accomplishments, and share their stories.
Strynadka LabAn avid movie enthusiast, Dr. Shoeib Moradi (he/him) is studying bacterial protein secretion apparatus, the typeIII secretion system (T3SS) of pathogenic bacteria at the atomic level. By structural elucidation of proteins that contribute to the formation of T3SS, he hopes to fully understand how bacterial virulence proteins are released into the cytoplasm of human host cells in order to help prevent intestinal diseases.

common in many pathogenic bacteria known as T3SS. This system secretes toxins into host cells such as humans and animals. In order to prevent bacterial infection and develop effective treatments, it is required to fully understand the T3SS mode of action and its assembly to find out how bacterial virulence effectors are directly delivered into the host cell.
What are some things you like to do outside of the lab?
Anything social or with nature – going to cinemas, bars, restaurants, camping, photography and hiking!
I am also a huge movie fan, especially for sci-fi and mystery. Every night I watch a few in my home, where I’ve designed my own theatre with a projector.
What is your favourite thing about science?
Tell us about a few achievements and awards that you are proud of.
What is your research about?
My current research focuses on proteins that are related to pathogenic bacteria.
I am a protein chemist: I study the structure of recombinantly produced proteins to understand the formation of large macromolecular assemblies at atomic resolution, using techniques like protein x-ray crystallography and single particle cryogenic electron microscopy (cryo-EM).
In the Strynadka Lab, I study a large needle-shape compartment which is
Science has no borders. It doesn’t have any limitations and every day you can discover something new. If this discovery takes years to be completed, there are still questions to pursue. Findings lead to more important questions, and that keeps me moving forward.
Tell us what sparked your interest in science.
A love of discovery! When you’re a kid, you want to discover new things, and this never stopped for me, especially for biology. We’ve discovered many solar systems, stars and different galaxies, but there’s so much we can still learn about our own body.
The biggest achievement is that I have been able to come this far in science, regardless of all the challenges. Doing a MSc, PhD or Postdoc is very difficult, and I am proud that my work contributes to a tiny part of public health.
For awards, I was very proud to receive the PSI-FELLOW-III-3i which is Horizon 2020 Marie Skłodowska-Curie COFUND Action Postdoctoral Fellowship, from the Paul Scherrer Institute in Switzerland (PSI). C
Shoeib Moradi Postdoctoral Research Fellow
We’ve discovered many solar systems, stars and different galaxies, but there’s so much we can still learn about our own body.
Dr. Grace Cole (they/she) is investigating the process of blood cell formation. In doing so, they hope to discover a method to produce blood cells in the lab for patients that need them.
Tell me about your research. My project involves the regulation of blood cell formation. Blood cells are formed in the arteries during embryonic development, through a process called endothelial to hematopoietic transition. Researching this process can help us understand how we can produce blood cells in the lab setting, which could help us generate new blood cells for patients – say, for those who need a stem cell transplant, but can’t find a suitable donor.
Many people who struggle to get a donor or stem cell transplant are of mixed ethnicities, or are underrepresented in donor registries. If we can produce a protocol that could generate blood cells for these populations, it would remove a lot of inequities. That’s another reason I’m really passionate about this project.
I’ve always loved trying to understand how things work, and that’s really what science is all about. More specifically, I love science and health research because I’ve always been interested in healthcare. Combining those two things –understanding of how things work, and health research – will hopefully allow me to contribute knowledge that will help improve people’s lives.
What sparked your interest in science?
I’ve always been very good at the sciences, which comes from natural interest – I did well in sciences, maths and technology in school. I did well in biology in particular, and liked understanding how the human body worked. It’s fairly safe to say I was awful at all of the arts subjects, so maybe that helped me pursue what I did in life!
My first degree was actually in pharmacy, not a hard science, as I was interested in being a healthcare professional. I learned about a very big research program while I was in school, and figured that doing health research is also a really good way to help people. That’s when I went back to pursue a PhD.

What are your favourite things to do outside of the lab?
I’m really into fitness and love the outdoors! My main sport is rowing, but I also jog along the seawall, snowshoe, hike, and weightlift. I enjoy reading, and have 2 cats that take up a lot of my free time!
Tell me about any awards you’ve received or any accomplishments you’re proud of.
I received a 2021 Michael Smith Foundation for Health Research (MSFHR) Research Trainee award, which is my biggest accomplishment and has given me 3 years of funding for my project.
During my PhD, I was at Queen’s University Belfast in Northern Ireland, which was funded by Prostate Cancer UK. I also had a postdoc that was funded for a year by the Medical Research Council of Northern Ireland. C

In the Kim Lab, Dr. Kalyan Golla (he/him) is uncovering the secrets behind platelet activation. He aims to develop therapeutics that can prevent platelets from forming deadly blood clots, while still preserving their role to stop bleeding from natural injuries.
Tell me about your research. Platelets are sticky and anucleat cells circulating in the blood. They initiate the process of blood clotting under both physiological hemostasis – the natural clotting process that stops bleeding – and pathological thrombosis – the formation of deadly blood clots. Therefore, it is important to understand the mechanisms involved in platelet activation. My research is focused on understanding the molecular mechanisms that control how circulating blood platelets contribute to hemostasis and thrombosis.
Platelets also need many proteins to carry out their functions. My research seeks to identify the role of several key proteins required
I’ve always loved trying to understand how things work, and that’s really what science is all about.
“
for platelet function. I aim to develop new antiplatelet agents to manipulate protein function and regulate platelet reactivity in thrombosis, while preserving hemostasis.
What are some of your favourite things to do outside of being a Postdoc?
What do you love about science?
I love science because I get to explore my curiosity and learn new things. As I learn, I don’t get answers, but instead get more questions.
What sparked your interest in science?
I have always been curious about the world we live in. As a child, I remember catching my interest in the traditional practices that my family followed to treat sickness. I was always curious about how the contents of natural food products contribute to human health, particularly during sickness.
My interest in science was sparked while I was in secondary school (because I did poorly in Mathematics). It was my biology teacher who taught me about the wonders of science. This led me down the road of studying biology and ultimately becoming a scientist.
Coming from a farmer’s family, I have always had a keen interest in learning about farming methods. I was actively involved in various farming activities until graduation. My favourite pastime is to read and learn about how technology can help to develop modern farming practices. Currently, I am a passive farmer, leveraging my research and problem-solving skills to develop novel farming methods.
Outside of the lab, Dr. Kerryn Matthews (she/her) is a huge hockey fan; inside the lab, she focuses on analyzing single cells using biology, imaging and machine learning tools.
Tell us about any Awards you have received or Achievements that you are proud of.
Being a non-English speaker, I have faced many language challenges in my research career. My biggest achievement is earning a PhD in an Englishspeaking country. C
Tell me about your research.
I’m focusing on analyzing single cells: trying to figure out why single cells do what they do, using biology, imaging, and machine learning tools.
Our lab is developing technologies to analyze and sort single cells for different applications. In one of our diabetes projects, for example, we’re looking at single cell secretion to understand which cells produce higher levels of insulin compared to others.
During my post graduate studies in South Africa, I came to Vancouver for a Keystone conference, and got to experience the best of the city. When I was looking for a postdoc, and saw Hong’s job posting, the location and mix between engineering and biology offered an exciting opportunity that we couldn’t pass up. Also, as a two-time stroke survivor, being here, in Vancouver and the CBR, feels almost like destiny! I’m fully recovered because doctors were able to remove the clot, which was an experimental procedure at VGH at the time.
Tell us what you enjoy the most about science.
* At the time of interview, Dr. Kalyan Golla was part of the Kim Lab; he is now part of the Pryzdial Lab.
If we can sort these cells, separate the high-secretion populations, and sequence them to understand what is mechanistically different about them, we can find out which cells are the most potent and useful for patients that need them.
I’ve always enjoyed understanding the how and why of something. Having a variety of projects and learning something new every day definitely keeps you young at heart! Science also offers opportunity to travel. I’ve been to so many wonderful places to present my research.
I love building stuff and collaborating with the engineers in our group has widened my research outlook. My very first week of work in Hong’s lab, I had to make a
Dr. Kerryn Matthews Research Associate
Multi-Scale Design Laboratory (led by Dr. Hongshen Ma)
I love science because I get to explore my curiosity and learn new things. As I learn, I don’t get answers, but instead get more questions.
“
Having a variety of projects and learning something new every day definitely keeps you young at heart!
“
microfluidic device by myself, which was awesome. When you’re working with engineers, nothing is a silly idea – you can always figure out how to improve a design and make it better.
What do you do outside of the lab?
From a young age, playing field hockey was my whole life. Recently I had to give that up, but I’m still very involved: I coach my sons field hockey team and I’ve started umpiring field hockey again. I also spend 8 months of the year at the rink watching ice hockey. You could say I’ve become a hockey mom!

Tell us about the awards or achievements that you are the proudest of.

I was one of the first students in Africa to receive a Wellcome Trust Fellowship, which I’m very proud of. I had my own funding for my PhD project, which meant that I also had the freedom to pursue my own ideas. It’s important for young researchers to have that opportunity. C
My name is Ahmed Kabil and I am a PhD research student at Dr. Kelly McNagny’s lab. My research involves developing several genetic mouse models that allows us to monitor the emergence development and history of innate lymphoid cells and then investigate how they regulate the state of health at mucosal barrier surfaces. Outside of the lab I enjoy playing soccer and listening to podcasts.

I am Deasung Jang, a PhD student in Mechanical Engineering under the supervision of Dr. Hongshen Ma. Ma’s research group is part of the Centre for Blood Research, and our research is involved in developing technologies for investigating biological systems at the scale of single cells.


I am a PhD Candidate working with Dr. Dana Devine to better understand how blood donor characteristics can influence the quality of transfusion products. With underlying interests in vascular contributions to Alzheimer disease, my project focuses on characterizing products from elderly and diabetic donors. I hope that this work will not only translate to refined policies within Canadian Blood Services and other blood services worldwide, but also contribute to a more fundamental understanding of how established risk factors for dementia may feed into disease via the vasculature. When I’m not in the lab, you can find me crabbing from my kayak at Jericho beach, mountain biking along the Sea to Sky, playing hockey in North Van, or trying to improve my Adobe Creative Cloud skills.
My name is Felix Hong, and I am a Master’s student in the Biochemistry and Molecular Biology program. Currently, I conduct research in the Kim lab, where I study this life-essential protein called filamin A in regulating platelet functions and signaling pathways. In my spare time, I enjoy doing a variety of different physical activities, such as basketball, badminton, and juggling!
The CBR Graduate Award Program (GAP) is an educational development program available to MSc and PhD students, providing successful applicants with funding, as well as a chance to develop professional experience that is useful in and beyond academia, like presentation, event organizing, and communication skills. READ MORE PROFILES ON THE NEXT PAGE >
My name is Henry, and I’m a Masters student in the Pryzdial lab where I research the exploitation of the procoagulant protein tissue factor by enveloped viruses. The goal is to establish tissue factor as a ubiquitous presence on the surface of enveloped viruses and support the development of drugs targeting tissue factor for use as antivirals. Outside the lab I enjoy backpacking, skiing, running, and am trying to learn some tennis.
I’m Loulou, a second year PhD student in the Côté Lab at UBC Hospital. My research looks at the potential toxicities that’s HIV antiretrovirals may exert in primary cell models. In my spare time, I enjoy volleyball, badminton, hiking, climbing, baking, and tending to my indoor plants.





I was born and raised in Fairfield, Connecticut, USA, but moved to Vancouver in 2014 for my undergraduate studies in Biology and Behavioural Neuroscience at UBC. A current graduate student in the Medical Genetics program, my thesis project in Dr. Wilf Jefferies’ lab involves modeling substance use and psilocybin therapy using neural organoids (“mini-brains”). I’m passionate about knowledge translation and representation in STEM, aspiring to demonstrate that success in academia isn’t restricted by gender, sexuality, or neurodiversity. Outside of the lab, you can find me hiking, camping, cycling, snowboarding, or otherwise embracing Vancouver’s sights and outdoor activities. Ask me about video games, fantasy novels, or her foster rabbits!
My name is Peyman and I have been doing a Ph.D. in Pathology and Laboratory Medicine in Dr. Kizhakkedathu’s lab since January 2022. I did my undergraduate degree in Chemical Engineering in Iran, but soon I changed my field of study to Material Science in my master’s degree in Europe and I am now here as part of CBR, doing research on “Bladder cell surface engineering and immunomodulation”. Similar to my academic interests, my hobbies also include a diverse range. I like to play table tennis, basketball, watch movies, play video games, read socioeconomic books and I really like to try anything new that comes my way.
Tell us about your research.
I work as part of an interdisciplinary team with Prof. Karen C. Cheung, Prof. Sudip Shekhar, and Prof. Lukas Chrostowski on developing accurate, quantitative technologies for diagnostic testing that are suitable for point-ofneed measurements, in places like remote and rural communities that are far from diagnostic testing labs. I work as a Mitacs Elevate Postdoctoral Fellow in the School of Biomedical Engineering and the CBR, and at Dream Photonics, Inc., a UBC startup company.
One challenge is that existing portable, low-cost diagnostics like COVID rapid tests don’t have the same accurate, data-rich results as tests that are run in centralized diagnostic labs. We are hoping to build a technology that brings those capabilities to remote environments, with the goal of helping clinicians make diagnoses and treatment decisions faster.
We use silicon photonics, a technology that has similar fabrication processes as those used to make silicon computer chips, but uses them to make optical and opto-electronic devices. With this technology, we can integrate tens of tiny optical sensors on a millimeter-scale silicon chip and get data-rich measurements of biomarkers.
Part of my job includes working with the team on designing and characterizing the photonics and
microfluidics, fabricating microfluidics, running assays, attaching bioreceptor molecules to the surface of photonic devices to turn them into sensitive, specific sensors, and developing electronics for readout of the sensors.
How did you feel when you found out that you received the award?
So overwhelmed by emotion – I really can’t articulate how much this award means to me! Mentorship is such an important part of my work, because we can do so much more by working together. Working with and learning from students is my favourite part of the job.
I’m honoured and immensely grateful to the students, the CBR, and the Neil Mackenzie Memorial Fund. Hearing that my team feels like I’ve inspired and helped them in their research makes me want to live up to the award.

How would you describe your mentorship style?
My goal is to not have one style – to be flexible. I try to tune my mentorship to the needs of each student, because everyone is different and has different goals. If I were to outline 3 qualities, they would be:
1. Continuing to learn how to be a better mentor. Just like in my science, I try to keep an open mind to new ideas and never assume I’m an allknowing expert. I want to always learn from experts and peer-reviewed literature, to build on what I already
know to better serve students.
2. Creating a culture where we inspire each other to succeed and ask hard questions. I want us to inspire each other to do our most rigorous science, but also cultivate curiosity and enjoyment, celebrate successes, and solve problems in a better way.
3. Understand that we’re all human. We’re all going to have bad days, some deliverables won’t be our best, and things are going to go wrong –that’s inevitable. I want to do what I can for the folks on my team during those times, and think: “OK, how can we adjust our training so that this is less likely to happen in the future?”
Things are going to go wrong, so it’s just risk mitigation and reframing mistakes from something bad to be ashamed of to a learning opportunity.
What’s the most challenging part of mentorship?
There is no one-size-fits all approach. We’re always learning, trying new things, asking for feedback, and compromising between different team members’ needs and styles to find the best solution for everyone.
What’s the most rewarding part of mentorship?
Feeling like I might have made a difference and given back a little bit of what’s been given to me.
Tell me about a formative mentorship experience early in your career.
I had a bit of a challenging time in undergrad. I felt I wasn’t a strong enough engineer and almost dropped out of my program. Looking back, I think many factors contributed to that feeling, like being a female student in a maledominated environment.
When I went into my first co-op, I wasn’t sure if I could be there. But my mentor, Prof. Karen Kavanagh at SFU Physics, guided me. She showed me what to
do in the lab, and helped me connect theories I learned in my courses to real-life applications. Using what I’d learned in my courses to solve real-life problems in the lab was central to me continuing my program, and I’m really grateful she made that environment. And my subsequent mentors helped me to build upon that confidence and those skills to get to where I am today.
What do you like to do outside of the lab?
I have a Chihuahua-Dachshund mix called Stanley, so I like to hang out with him and go for walks, hikes, and snowshoeing adventures. I also enjoy swimming, paddleboarding, board games, and baking (Zoom baking with friends, too!)
What are your parting words on mentorship?
Mentorship has had a transformative impact on my own growth, and every day I’m grateful for the opportunity to try and give back some of what my mentors have given me.
Dr. Samantha Grist would also like to thank the following people, who have also been key mentors in her life: co-op mentors Dr. Greg Hackman and Ken Jessen; undergraduate thesis supervisor Prof. Bonnie Gray; PhD cosupervisors and current co-supervisors Prof. Karen Cheung and Prof. Lukas Chrostowski; current co-supervisor Prof. Sudip Shekhar; previous postdoctoral supervisor Prof. Amy E. Herr; and countless colleagues, informal mentors and students that she’s had the privilege of working with and learning from along the way. C
Learn more about the award at: www.tinyurl.com/cbrneilmackenzieaward
Right:
Anon-linear path in life is sometimes key to opening many unexpected opportunities. This is the case for Dr. Katharine (Kate) Sedivy-Haley, a PhD alum of the Centre for Blood Research (CBR). Dr. Sedivy-Haley recently graduated from the PhD program for microbiology and immunology at the University of British Columbia. At the time of the interview, Dr. Sedivy-Haley was a Researcher at the Council of Canadian Academics (CCA); she is currently a Policy Advisor at Innovation, Science, and Economic Development Canada (ISED).
We had the opportunity to chat with Dr. Sedivy-Haley about her journey through grad school and her experience with career exploration, as well as her transition from academia into science policy.

How did you choose your PhD topic?
My original project examined macrophage polarization and innate defense regulator peptides, a topic that the Hancock lab has been studying for some time. These synthetic peptides are similar to natural peptides that regulate macrophage immune function. Originally, we planned to investigate the mechanisms behind this regulation by studying gene knockout macrophages derived from stem cells, but ran into complications.
Around this time, one of our collaborators was developing a Salmonella infection model in the stem cell derived macrophages. Dr. Hancock and I decided that instead of the original project idea, it would be a great opportunity for me to use this Salmonella infection model to study another topic of
interest to the lab: endotoxin tolerance, which is associated with the disease sepsis.
Using that Salmonella model in my project, I compared three activation states for macrophages: traditional inflammatory M1 type macrophages, the wound healing M2 type, and the endotoxin tolerant type. I found that these three types of macrophages expressed different genes, both as a baseline and in response to being infected with Salmonella. These differences in gene expression could explain differences in how well the macrophages fight the infection.
How did your experiences in the Hancock lab inform your scientific perspective?
One of my key takeaways was developing curiosity around broad scientific concepts.
My project had a narrower immunology focus at first, but as it evolved, it brought in aspects of microbiology and bioinformatics. Shifting from subdiscipline to subdiscipline helped broaden my perspective, which is important whether you’re working inside or outside of academia.
If you could go back to the beginning of your PhD, what advice would you give yourself? That, ultimately, I could choose not to pursue academia. Starting my PhD, I thought I wanted an academic career, but the more I learned about different career options, the more I realized that I didn’t want to head in that direction.
I didn’t start looking into alternative career options until halfway through my program. If I had done more exploration earlier on, I would have developed other, non-research skills more consistently throughout my degree and networked with diverse experts about their career paths, instead of thinking that I had to focus all of my energy on my research project.
During your time in graduate school, did you feel like there was enough emphasis on knowledge translation?
I would say that there was enough emphasis, but we need to better integrate knowledge translation programs into the graduate student experience, instead of having them as “add-ons”. I don’t think these programs have to be mandatory, as not everyone enjoys them, but we do need to recognize the value they offer to science, and make it easier for interested students to find them.
During a CBR career development workshop, I completed an individual development plan, which helps people identify different career paths. Policy was listed as one of my top options, and, until that point, I hadn’t even realized it was a career option available to me.
I started looking more into policy, and attended a fascinating conference organized by the Science and Policy Integration Network, where leading experts spoke about provincial policy issues like the opioid crisis. At the Canadian Science Policy Conference, I also interacted with diverse people who were engaged in national science policy issues, and that helped me understand science policy more broadly. Later, I also got involved in student government through the UBC Graduate Student Society, which
was a neat way to learn about policy structures that affect students.
The more I explored science policy, the more confident I became that it was something that fit really well with my personal and work interests.
Tell us what it was like to apply and transition into your role at the Council of Canadian Academies.

The Council of Canadian Academies (CCA) is a small, nonprofit organization that creates reports on science policy issues, as commissioned by government departments and other organizations. I first found out about the CCA at the Canadian Science Policy Conference, where I talked to CCA employees about their internship program.
At that point, I had a shortlist of policy opportunities that I’d identified, and I applied for several, including the CCA. The CCA application required a writing sample along with a traditional resume – that was interesting to put together, and my writing practice with the CBR made it easier.
I was very excited to get the offer, and although this was a short, six-month position, it turned into a 1-year Researcher contract. I love working in a job that contributes to issues like international best practices for science funding, which will impact many others.
What does a typical workday look like for you?
Heavy research and reading lots of literature. This includes academic articles and the “grey literature”, like reports from government, industry, the OECD and the Government of Canada. I’m often sitting with a 30-page report chapter on one side of my screen and various PDFs on the other, highlighting important ideas and making bullet-point notes.
To produce a report, the research team conducts an initial literature review to gather sources, then we summarize key findings for an expert panel, who discuss any gaps in the literature review and topics that require more nuance. We then put together another draft with additional evidence to address their feedback, and
continue to revise it, with the panel’s expertise, until a consensus is achieved.
Although there’s a lot of independent research, writing and reading, my colleagues and I also collaborate and provide feedback on each other’s chapters, before the report is sent for the panel to review. Depending on the stage of our project, we also have specific tasks for fact-checking, publication and proofreading.
What were some programs that helped you develop your communication skills during grad school?
Blood Labs program: Organized by the CBR Outreach Committee, this program brings fun, blood-related science activities to schools in the Lower Mainland. I presented activities and answered questions from curious students – sometimes unexpected ones! It’s like presenting in a scientific context, but with more emphasis on “big picture” ideas that are important for general audiences, and less on technical details.
CBR Knowledge Translation Committee: I wrote summaries of research articles or topics that I found interesting but weren’t directly related to my research. This challenged me to quickly develop a baseline understanding about unfamiliar topics and summarize new information, so general audiences could understand scientific issues and concepts easily.
UBC Three Minute Thesis (3MT): This event helps you distill ideas and present them in a short amount of time. Overall, it’s a good activity to get yourself out there to strengthen your public speaking skills!
Can you tell us about one of your recent projects?
I worked on a CCA report on the circular economy in Canada, commissioned by Environment and Climate Change Canada. This circular economy is both an economic and environmental concept, and we are investigating how products can be created and used more sustainably, while still contributing to the economy. Putting that together has been a big experience, and it’s exciting to see the final result.
Interesting! What about your longer-term career goals?
For long-term career goals, I’m still figuring out things out. During my early career exploration, I looked at policy more generally: What’s out there? What should I be looking into? What does this type of work involve? I’m still getting a picture of career trajectories within policy, because it’s more complex than a typical professor-track path in academia with well-defined career stages.
One thing I’m interested in is leadership and project management. While I enjoy the deep writing and research in my current work, it might be interesting to shift again at some point in the future. Overall, exploration has been a big part of my career path, and I’m definitely continuing to keep an open mind.. C
Visit the CBR alumni spotlight page at: www.cbr.ubc.ca/alumni/alumni-spotlights/

families, and tumours contain both hereditary and tumour-specific variants. If we are able to differentiate between hereditary and tumour-specific variants in tumour DNA, we can save on cost and time because we only need to analyze the patient’s tumour DNA to acquire information on both variant types.
That’s really interesting! Tell us about your career path afterwards. How did you get your current position?
Invent the Future: A summer enrichment program focused on artificial intelligence for trans and cisgender women, non-binary and two-spirit students from Grade 9-12.
STEM Speaker Series: Graduate and undergraduate students present their projects to high school students.
When you were younger, did you ever attend a life-changing science camp? Or a STEM program that sparked your curiosity? Eva Yap, a CBR alum, is doing exactly that: creating programs and opportunities for youth to get excited about science.
As an Outreach Programs Coordinator in SFU’s Faculty of Applied Sciences, Eva oversees a variety of science programs aimed at youth from K – 12. We sat down with Eva and asked her about her career path – from her MSc in the Karsan Lab, to her post-grad job search, to developing outreach programs for kids today.
What did you study in grad school?
I did my MSc in Experimental Medicine from 2014 – 2017, on a computational biology project in the Karsan Lab. My graduate research was focused on cancer and genetics. I aimed to figure out if a genetic variant in a formalin-fixed paraffinembedded (FFPE) tumour is hereditary (meaning that the variants are found in normal cells) or tumour-specific (meaning that the variants are found in tumour cells only).
Hereditary genetic variants have clinical impacts on cancer patients and their
After graduating, I worked at Genome BC Geneskool, delivering genomics and genetics outreach programs. It was super aligned with my grad school (and even undergrad) studies!
I’ve always enjoyed being an educator, so I also completed a Master’s of Education at SFU, with a focus on educational technology and learning design. While I was there, I saw and applied for new job opportunity in the Outreach Department of SFU’s Faculty of Applied Sciences, which is where I am now!
I was hired to run SFU Science AL!VE, an outreach program in the Faculty of Applied Sciences that focuses on K-7 programs. As part of the Faculty’s efforts to engage high school students, my portfolio now focuses on creating and overseeing more programs for youth in high school. Just a few of these include:
App Dev Workshop: A program where kids develop mobile apps; some are co-ed, others are all-girls.
Pepper Academy: Students program this semi-humanoid, fridge-sized robot called Pepper, which can identify emotions.
Applied Sciences After Dark: Members of the public can learn how to code. I started this series because I realized that a lot of parents want to support their kids’ coding interests but don’t know how, so this provides them with basic coding skills.
The biggest challenge was definitely when COVID hit, and I had to convert all our activities to a virtual format. I was hired to run in-person programs, and I didn’t have any experience with Zoom events or programs. It was a steep learning curve, but I think my educational technology education helped a lot.
Another challenge is managing everything I have to do. I develop curricula and promote our programs, but also perform operational work like budgeting, buying materials, setting up registration, following up with parents, and hiring and training my staff.
Last summer, I was overseeing 17 staff, so I have to make sure that they are trained, supported, and feel like they’re developing in a way that’s meaningful to them. It’s very challenging to manage all that, but on the flipside, I enjoy doing a variety of things.
My favourite part of the job is seeing youth excited about STEM and wanting to learn more, and helping my staff succeed in their roles. That’s the most rewarding thing!
When did you realize you wanted to do outreach, rather than labwork?
I don’t think there was really a single, defining point where I felt like I didn’t want to work in a lab. I liked science outreach but I also liked computational biology, so I applied for jobs in both areas, and took the Geneskool opportunity when it was offered to me. Things just kind of fell into place!
When you were a student, what did you value the most about your time at the CBR?
The CBR Graduate Award Program (GAP) was a lot of fun. We explored different scientific topics through the Program’s journal club, including ones I might not have been exposed to in my lab. Since I was located off-campus at the Genome Sciences Centre, GAP made me drag myself to UBC and talk to people there!
As part of GAP, my cohort put together an “When Arts Meets Science” event, with a “paint your thesis” activity and a keynote talk about science communication. I feel like that actually helped me get my current position, because I was getting a lot of relevant experience by organizing event logistics and inviting speakers, which I still do now.
My fellow lab mates! Some of them are really amazing people who provided lots of advice on my grad school project. We still keep in touch and support each other, and sometimes I’ll even ask for feedback on outreach activities I’m planning.
If you could go back in time and give your grad school self any advice, what would you say?
In grad school, I think there’s a lot of pressure to achieve as much as possible, as quickly as possible, and also to try and fit a certain mould. Like you have to do a PhD, then more science, then more research – that’s portrayed as the favoured career path.
Looking back, I would have told myself to take my time, and that life is not a race. Everybody’s path is different, so don’t
worry too much and try not to compare yourself to other people. Your journey is your own.
How did you get involved with outreach programs?
UBC has some organizations like Let’s Talk Science and the CBR Outreach Committee. I actually volunteered with Geneskool before I got hired there, and I feel like my previous experience helped, as I was familiar with the program already.
There’re so many opportunities out there, so sign up for newsletters, talk to people, and volunteer. You never know who you’ll meet –one conversation could lead to your next job!
In your role, you do a lot of science communication, especially for K – 12 youth. Why is this important for scientists? Do you have any advice for trainees?

You know your own research best. But in science communication, you have to make that research understandable to an audience, and hold their attention for maybe 20 minutes. It’s not as easy as it seems!
At the end of the day, the people who are impacted by your science are members of the public. They have different experiences and needs than an academic audience.
It’s really important to understand that, and to be able to explain your project comprehensively to them in a short amount of time.

I’d challenge trainees to participate in outreach programs and explain their science to high school students. Kids are very honest with their thoughts – if they’re confused, they will tell you, so it’s good practice for answering questions, too.
What are your tips for approaching a job search process?
My key piece of advice is to tailor your resume and cover letter to each job you apply to. Now that I’m responsible for hiring people, I’d say it’s very easy to tell if someone’s tailored their application to your job posting and organization.
So do your research! What are the organization’s values? What is their mission
and vision? Write your cover letter with that in mind, and tailor your resume to show that you have the skills to do what they need you to do in the job description.
What advice do you have for students who are transitioning to a workplace outside of academia?
Find a mentor. Talk to them about their experiences, go to career events, and meet other people. In school, people often see degree completion as the endpoint, but it’s always good to think ahead.
Don’t give up! Not everyone has a straightforward career route. You might apply for a few jobs and not get them, so you have to apply for more until you get an offer… and all the while, life is happening! While it may sound cheesy, I would say: don’t give up, even when things don’t go your way. Just keep pushing forward. C
Bottom:
We were thrilled to receive a range of creative responses and visuals in our cover art submissions.
Left to right, top to bottom:






“Monocytes in Action”
Matthew Drayton, Research Assistant, Kizhakkedathu Lab
The monocyte monolayer assay is often used to determine the compatibility of red blood cells (RBCs) for blood transfusion. In this case, A-type RBCs are opsonized with anti-A antibodies from an O-type donor’s serum; the monocytes recognize the antibodies coating the RBCs and engulf them.
“Picrosirius red staining of collagens in mouse fat tissue”


Nooshin Safikhan, Research Assistant, Conway Lab Picrosirius red staining of collagens show fibrosis (ECM deposition) in white adipose tissue of wild type CD248 mouse after feeding with High Fat diet (HFD) for several weeks.

“To B Human”

Matthew Drayton, Research Assistant, Kizhakkedathu Lab




This is a human kidney section from a blood type B donor. Cell nuclei are stained blue, and B antigens are stained red.
“The joy of studying things we don’t see” Jimin Jung, MSc Student, Brömme Lab
I love research and studying things we don’t see by our naked eyes. Here, I drew some things we might not see in person (without microscopes), but we know that they exist by wonder of research (osteoclasts, red and white blood cells, viruses, antibody, and mitochondria).















Dr. Dana Devine appointed as President of the Biomedical Excellence for Safer Transfusion (BEST) Collaborative

In September 2022, Dr. Dana Devine commenced her four-year term as President, two decades after she attended her first meeting with the international research organization.
Dr. Jayachandran Kizhakkedathu receives 2022 Faculty of Medicine Distinguished Achievement Award
Dr. Jayachandran Kizhakkedathu received his award in the Excellence in Basic Science Research category, which recognizes outstanding basic science research and scholarly contributions in the areas of health and life sciences.
Dr. Reinhild Kappelhoff champions lab sustainability with glove and mask recycling project
With $1000 from the Workplace Sustainability Fund, Reini was able to purchase 7 boxes for mask and glove recycling, which she then distributed to different Centre for Blood Research labs.
Dr. Fabio Rossi elected to the Royal Society of Canada
Dr. Fabio Rossi is among 102 new Fellows elected to the Royal Society of Canada (RSC) in recognition of his outstanding scholarly and scientific achievement.
Aly Karsan awarded a UBC Killam Research Prize for 2021
Dr. Karsan was 1 of 4 UBC Killam Research Prize recipients from the applied science, medicine and sciences area, in the Senior Category.
Read about more awards and accolades at: www.cbr.ubc.ca/category/news/awards/
We would like to thank our sponsors for their generous support, without whom the Earl W. Davie Symposium and CBR Programs would not have been possible:
Centre for Blood Research












4th Floor, 2350 Health Sciences Mall Vancouver, BC Canada V6T 1Z3
